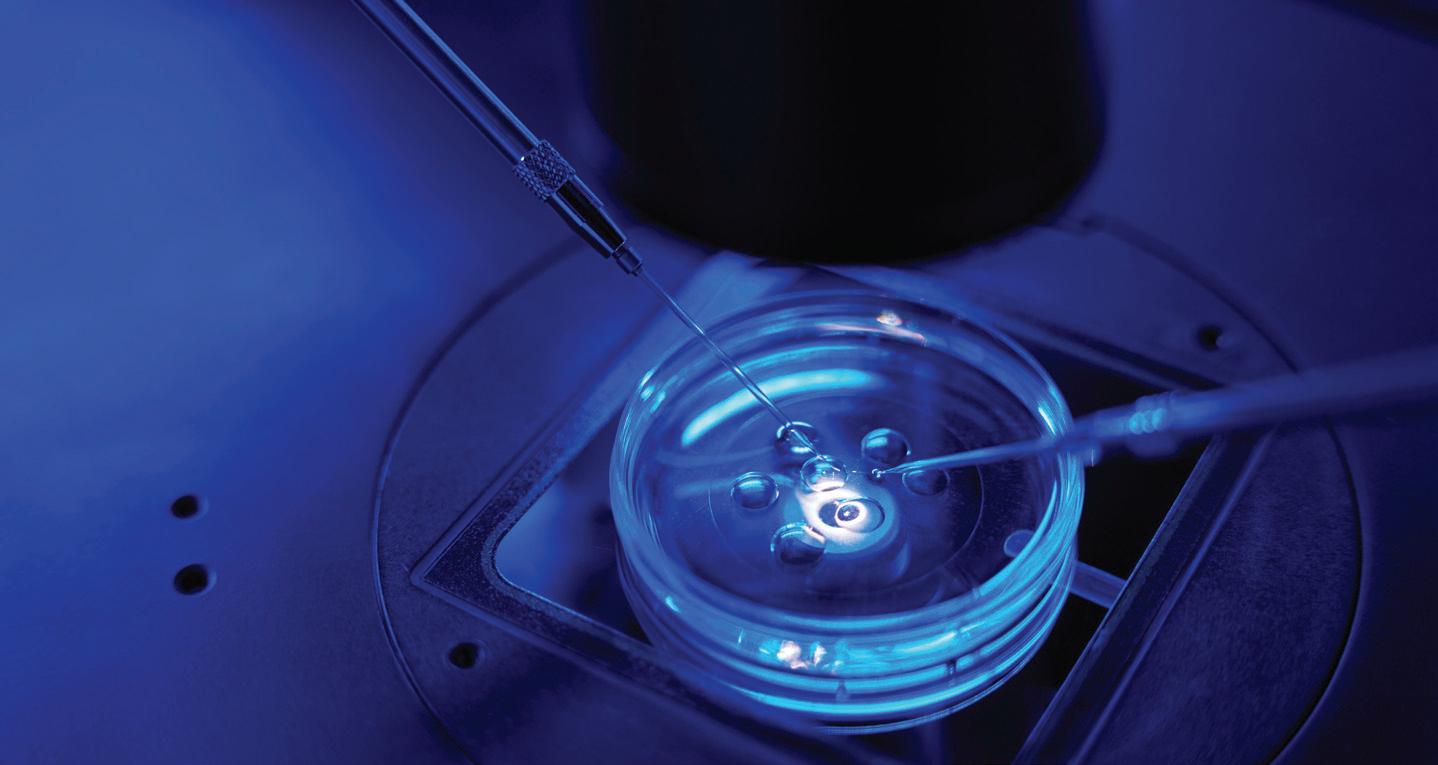

AsTheBoringCompany’s Music City Loop tunnels forward, we explore thecompany ’ s trackrecord,thetunnel’s environmental impac t and the politics surroundingtheproject




IVF Clinics, Patients Caught in Legislative Crossfire
Advocates bristle at fetal personhood legal ramifications, as well as government oversight in testing, certification BY HANNAH HERNER
Pith in the Wind
This week on the Scene’s news and politics blog Metropolitik: View From a Broad Writes the Scene’s former editor-in-chief, from Boner to O’Connell, the city has become easier to explain and harder to recognize BY LIZ GARRIGAN
Survey Assesses Language Access in Nashville
Metro Human Relations Commission is evaluating how accessible Metro departments are to those not fluent in English BY ALEJANDRO RAMIREZ
COVER PACKAGE: OUT OF THE LOOP
Political Tensions Brew as Music City Loop Progresses
State vs. Metro power struggle persists as state and local leaders fight for control over tunnel project BY JULIANNE AKERS
Inside the Weird, Overhyped World of The Boring Company
A warning from a Las Vegas Loop critic: ‘Don’t take the bait’ BY NICK PIPITONE
Talking About the Music City Loop With an MTSU Geoscientist
Professor Mark Abolins talks about Nashville’s challenging bedrock BY ALEJANDRO RAMIREZ
CRITICS’
Gillian Welch and David Rawlings, Zara Larsson, Possum Party, Panda Fest and more
FOOD AND DRINK
Date Night: GreenHouse and El Palenque
Grocery shopping your way through Green Hills? Make a night of it. BY DANNY BONVISSUTO
The Trinket Revolution
A Shop of Things rallies Nashvillians in the name of nostalgia BY MADELEINE BRADFORD









MUSIC
Practical Magic
Jessye DeSilva’s Glitter Up the Dark revels confidently in queer joy BY BEE DELORES
Ancient Rhythms of the Future
Ibro Dioubate, Jeff Coffin and company get ready to bring the kinetic sound of West Africa to the Nashville Jazz Workshop BY SEAN L. MALONEY
The Spin
The Scene’s live-review column checks out Big Ears Music Festival in Knoxville BY JASON SHAWHAN
FILM
Through the Looking Glass
Christian Petzold’s Miroirs No. 3 is the sort of family drama we don’t see enough of anymore BY CRAIG D. LINDSEY
NEW YORK TIMES CROSSWORD AND THIS MODERN WORLD


dining experience from Prime + Proper during the Music City Food & Wine Festival. Reservations are now open for April 22 and 23. musiccityfoodandwinefest.com

RED, WHITE AND BLOOMS AT CHEEKWOOD Celebrate spring at Cheekwood’s Red, White and Blooms,

POWER OF THE PURSE Step into a celebration of generosity at The Power of the Purse


SUBSCRIBE
NEWSLETTER: nashvillescene.com/site/forms/subscription_services
PRINT: nashvillesceneshop.com
CONTACT
TO ADVERTISE: msmith@nashvillescene.com
EDITOR: prodgers@nashvillescene.com



with performers including Skrillex, Noah Kahan, The Strokes, Rüfüs Du Sol and many more. nashvillescene.com/promo/freestuff

















In my 35+ years living and working in Nashville, I’ve navigated the twists, turns and now expansive growth of this wonderful place. Let me help you make the best choices in your biggest investment — real estate. I’m so grateful for my clients’ great reviews, repeat business and continued referrals. I’d love the opportunity to help make your Real Estate Goals a reality!














EDITOR-IN-CHIEF D. Patrick Rodgers
MANAGING EDITOR Alejandro Ramirez
SENIOR EDITOR Dana Kopp Franklin
ARTS EDITOR Laura Hutson Hunter
MUSIC AND LISTINGS EDITOR Stephen Trageser
ASSOCIATE EDITOR Logan Butts
AUDIENCE EDITOR Annie Parnell
CONTRIBUTING EDITOR Jack Silverman
STAFF WRITERS Julianne Akers, John Glennon, Hannah Herner, Hamilton Matthew Masters, Eli Motycka, Nicolle Praino, William Williams
SENIOR FILM CRITIC Jason Shawhan
EDITORIAL INTERN Jasmin Enriquez
CONTRIBUTING WRITERS Cat Acree, Sadaf Ahsan, Ken Arnold, Ben Arthur, Radley Balko, Bailey Brantingham, Ashley Brantley, Maria Browning, Steve Cavendish, Chris Chamberlain, Rachel Cholst, Lance Conzett, Hannah Cron, Connor Daryani, Tina Dominguez, Stephen Elliott, Steve Erickson, Jayme Foltz, Adam Gold, Kashif Andrew Graham, Seth Graves, Kim Green, Amanda Haggard, Steven Hale, Edd Hurt, Jennifer Justus, P.J. Kinzer, Janet Kurtz, J.R. Lind, Craig D. Lindsey, Margaret Littman, Sean L. Maloney, Brittney McKenna, Addie Moore, Marissa R. Moss, Noel Murray, Joe Nolan, Katherine Oung, Betsy Phillips, John Pitcher, Margaret Renkl, Daryl Sanders, Bobbie Jean Sawyer, Nadine Smith, Ashley Spurgeon Shamban, Amy Stumpfl, Cole Villena, Kay West, Nicole Williams, Ron Wynn, Kelsey Young, Charlie Zaillian
ART DIRECTOR Elizabeth Jones
PHOTOGRAPHERS Angelina Castillo, Eric England, Matt Masters
GRAPHIC DESIGNERS Sandi Harrison, Tracey Starck, Mary Louise Meadors
GRAPHIC DESIGN INTERN Torian Staggs
PRODUCTION COORDINATOR Christie Passarello
MARKETING AND EVENTS DIRECTOR Robin Fomusa
EVENTS MANAGER Tristan Maryanski
BRAND PARTNERSHIPS AND EVENTS MANAGER Alissa Wetzel
MARKETING AND PROMOTIONS MANAGER Meredith Grantham
PUBLISHER Mike Smith
ASSOCIATE PUBLISHER Michael Jezewski
SENIOR ADVERTISING SOLUTIONS CONSULTANTS
Teresa Birdsong, Olivia Britton, Carla Mathis, Heather Cantrell Mullins, Niki Tyree
ADVERTISING SOLUTIONS CONSULTANTS
Kailey Idziak, Allie Robbins, Andrea Vasquez
SALES OPERATIONS MANAGER Chelon Hill Hasty
ADVERTISING SOLUTIONS ASSOCIATES Audry Houle, Jack Stejskal
SPECIAL PROJECTS COORDINATOR Susan Torregrossa
PRESIDENT Mike Smith
CHIEF FINANCIAL OFFICER Todd Patton
CORPORATE CREATIVE DIRECTOR Elizabeth Jones
IT DIRECTOR John Schaeffer
DIGITAL DIRECTOR Caroline Prater
CIRCULATION AND DISTRIBUTION DIRECTOR Gary Minnis FW PUBLISHING LLC


This Harvey Krantz–designed outfit, embellished with embroidery, rhinestones, studs, and mirrored discs, was worn by Country Music Hall of Fame member Barbara Mandrell in the late 1970s.
From the exhibit Sing Me Back Home: Folk Roots to the Present artifact: Courtesy of Barbara Mandrell artifact photo: Bob Delevante



Athena at the Park isn’t just a place to live–it’s a statement. Perched above West End with panoramic views of downtown and the Parthenon, these 51 luxury residences are designed for those who expect more. More space. More style. More experience. From the rooftop Sky Lounge to the resort-style pool and sauna, every amenity speaks to elevated living.
LUXURY CONDOS FROM $1.1M WEST END

Welcome to Stonewall, the newest development in Brentwood. These newly constructed masterpieces offer a perfect balance of comfort, style, and functionality just 12 minutes from Downtown Nashville and moments to Brentwood’s best shopping and dining. Step inside through the striking pivot front doors and immediately feel the warm elegance of white oak hardwoods, designer lighting, and curated stone surfaces throughout.
LUXURY HOMES FROM $1.8M BRENTWOOD

Advocates bristle at fetal personhood legal ramifications, as well as government oversight in testing, certification BY
HANNAH HERNER
CLOSE-UP OF INTRACYTOPLASMIC
SPERM INJECTION BEING PERFORMED IN A PETRI DISH
A BILL MAKING its way through the Tennessee General Assembly seeks to separate the definition of human life from that of artificial intelligence. But one clause in the legislation raised alarm for the group Tennessee Fertility Advocates: language asserting that life begins at fertilization.
“If ‘personhood’ passed — if any language passed with ‘personhood’ in there — IVF would be [over] in the state of Tennessee,” says Mollie Walker, co-founder of Tennessee Fertility Advocates, an organization supporting fertility care access and insurance coverage.
Last year, Tennessee became the first state to enshrine access to in vitro fertilization into law. However, several bills introduced in the Tennessee General Assembly this year — in their original language — would have complicated that access.
Language asserting life starts at fertilization was ultimately removed from the bill, to the relief of those in the IVF space — and this is despite the fact that many of these advocates are Christians who believe spiritually that life begins at conception.
Fertility advocates don’t want a repeat of what happened in Alabama in early 2024. After three couples sued a clinic that had accidentally destroyed their embryos, the Alabama Supreme Court ruled that frozen embryos are legally considered children. Because of this, several fertility clinics paused operations for fear of additional legal struggle. Alabama quickly passed legislation protecting IVF providers, allowing them to resume services in the months following.
Earlier in this year’s legislative session, another bill on fetal personhood failed in committee following intraparty division among Republicans and protests from dozens of out-of-state “abortion abolitionists.” If passed, that legislation would have applied fetal homicide charges to women who get an abortion.
The National Embryo Donation Center, headquartered in Knoxville, provides another option for families with frozen embryos they did not use in IVF: embryo donation. The center, founded
That’s another issue Tennessee Fertility Advocates does not want to see legislated.
“It is just an entryway for the government to continue to get into the reproductive system with legislation, and we want it to be between a patient and their doctor, and not involved with the government,” Walker says.
“
“IF ‘PERSONHOOD’ PASSED — IF ANY LANGUAGE PASSED WITH ‘PERSONHOOD’ IN THERE — IVF WOULD BE [OVER] IN THE STATE OF TENNESSEE.”
—MOLLIE WALKER, COFOUNDER OF TENNESSEE FERTILITY ADVOCATES
in 2003, facilitates 150 to 180 adoptions of those embryos per year. Currently, the center is storing 500 sets of embryos (each set containing two or more from the same donors) and more than 1,500 single embryos on ice. This is according to National Embryo Donation Center president Dr. Jeffrey Keenan.
Keenan expresses concern that the center could be charged with homicide or manslaughter were there a mistake in the lab, or if an embryo that could never fully develop were discarded.
“I do believe that life begins at conception,” Keenan says, citing his Christian faith. “However, I also understand that in normal fertilization, as well as in vitro fertilization, there are a large number of fertilized eggs and early embryos that never make it to birth, and could never make it to birth because of genetic and other abnormalities. To call every one of those embryos a human life is, I think, a mistake.”
He continues, “The problem is, if you treat these embryos as if none of them are human life, then you’re going to be potentially abusing or discarding a lot of human life.”
Another bill, Senate Bill 2461, before amended, would have limited genetic testing in embryos.
SB 2461, as it stands, would require additional certification for fertility clinics, including becoming members of the Society for Assisted Reproductive Technology. The National Embryo Donation Center’s counterpart, Southeastern Fertility Clinic (where IVF procedures take place), is not a member, at least in part because it adds a “significant amount of cost to each patient’s cycle,” Keenan says.
Locally based author Karen Kingsbury explores the concept of embryo adoption in her Christian romance novel Someone Like You, which was adapted into a film in 2024. In the story, the protagonist finds out she was an adopted embryo and searches for her biological family, ultimately discovering that her biological twin sister had died. That kind of story is possible but not probable, Kingsbury tells the Scene
Through her One Chance Foundation, Kingsbury provides scholarships for mainly domestic adoptions, but has also helped families with international adoptions and embryo adoptions. Her interest in the topic began with an article she wrote while she was a reporter for the Los Angeles Times in the late ’80s. During a custody battle over a frozen embryo, Kingsbury was invited into a lab to see an embryo in person.
“Everyone is going to come at it from their worldview and their level of faith or spirituality toward unborn babies,” Kingsbury says. “I think that’s going to be a personal thing they’re going to be thinking about. It was a big enough question that people were wondering about the morality of what to do with it, even back then.”
She continues: “My mindset on that is, it’s a life, this child. If that’s the situation, then you aren’t throwing them down the drain.”
Sen. Jeff Yarbro (D-Nashville) was the sole vote against SB2461 in the Senate Health and Welfare Committee.
“Almost everybody in Tennessee supports families’ right to seek IVF treatment, and yet in Tennessee, we continue to see year after year, new big efforts to overhaul the rules that apply to IVF clinics,” Yarbro said at a recent press conference. “That doesn’t provide the stability for these clinics to actually know that they can safely operate in Tennessee. It doesn’t provide the security that Tennessee families need to know that those clinics will be in place and have rules and be able to continue treating them over the course of their treatment.” ▼
Two last-second 3-pointers from Vanderbilt stars Aubrey Galvan and Mikayla Blakes didn’t fall on Friday, ending a historic winning season from the Vanderbilt women’s basketball team The lower-seeded Notre Dame Fighting Irish led by superstar Hannah Hidalgo, took out the Commodores in the Sweet 16 thriller, Vanderbilt’s best tournament program finish in almost 20 years. In the postgame press conference, sophomore Blakes and rookie Galvan were already looking forward to next year. The team heaped praise on coach Shea Ralph — winner of multiple NCAA coach-of-the-year accolades — who in turn credited athletic director Candice Storey Lee, who captained the Vanderbilt basketball team in its heyday. University athletics are experiencing a resurgence under Lee, with successful seasons this year from men’s basketball, women’s basketball and the Commodores’ often lagging football team.
A new bill advancing in the state legislature would require certain medical providers to report on transgender patients. Opponents, like the Tennessee Equality Project, say the legislation is pursuing a “registry” of trans people under the Tennessee Department of Health Rep. Jeremy Faison (R-Cosby), the bill’s Republican sponsor, publicly ridiculed gender transition and maintained that any data collected would be HIPAA-compliant. The state has been subject to multiple controversies and lawsuits related to anti-trans lawmaking and made headlines in 2023 for seizing 106 patient records from Vanderbilt University Medical Center
Seven pedestrian deaths in a four-week span have underscored the limited local progress on Mayor Freddie O’Connell’s Vision Zero plan for roadway safety. The March 16 hit-and-run death of Clifford Coleman on Ewing Drive capped a particularly deadly stretch for Nashville, which has identified the county’s most dangerous streets for years but faces a long backlog of traffic safety projects. Members of the city’s Vision Zero Advisory Committee say the mayor’s office, city transportation department and councilmembers have struggled to find alignment on roadway safety priorities, leading to insufficient, delayed or dismissed responses to traffic incidents across Nashville.
Thousands crowded downtown on Saturday for a national No Kings rally against the Trump administration. Community leaders, activists, musicians and several 2026 Democratic Party candidates addressed the crowd at Wasioto Park before marching across the river to Public Square Park Signs and remarks directed outrage at the Trump administration over issues including the Epstein files and the recent war launched by the U.S. and Israel against Iran










Writes the Scene’s former editorin-chief, from Boner to O’Connell, the city has become easier to explain and harder to recognize
BY LIZ GARRIGAN
Metropolitik is a recurring column featuring the Scene’s analysis of Metro dealings. Liz Garrigan lives in Bangkok, Thailand, and served as editorin-chief of the Scene well before Nashville was a bachelorette destination.
VIEWED HISTORICALLY, the outrage over Mayor Freddie O’Connell’s recent comments about rising property taxes — specifically as they relate to Acme Feed & Seed — feels like a giant nothing burger. If this is what passes for controversy these days, God help our Metro reporters.
It’s been nearly four decades since the city elected Bill Boner, a personality who perhaps a third or more of contemporary Nashvillians have never even heard of — an East Nashville boy who became a teacher before being elected first to U.S. Congress, and then to the city’s top job. Once there, his extramarital engagement to lounge singer Traci Peel overshadowed his tenure and made him a national laughingstock. (To this day he remains the namesake of the Scene’s annual list of blunders, the Boner Awards.)
For the past two-and-a-half years, the city has been led by a personality who could not represent a sharper contrast — a mayor whose greatest liability may be an excess of earnestness. The gap between these two men transcends disposition and character and tells a story of what Nashville used to be, and what it has elected to become.
Remembering Boner is instructive, because the Boner-to-O’Connell arc tells us everything we need to know about Nashville’s social and cultural metamorphosis.
Boner was a familiar type for Nashville in the 1980s, when it was a place where the most valuable currency was relationships, not necessarily competence. Some of the details that would come to define him are shopworn by now — the tabloid-ready romantic life, the engagement that arrived before the divorce, the appearance on The Phil Donahue Show. It became inseparable from his story. He was a scandal, but he was our scandal. You didn’t have to approve of him to feel like you understood, or at least knew, him.
That kind of familiarity used to matter more than virtually anything else. Though Boner’s open disregard for the social mores that tend to govern the behavior of married people made many locals bristle after his election, Nashville was smaller then, more insular, less concerned with how it appeared to people who didn’t


already live here. How else to explain how in the 1987 mayoral election, Boner — a Middle Tennessee State University graduate whose congressional tenure was marred by an ethics investigation — bested the Harvard-educated Phil Bredesen, who’d made a mint in the health care business and was cleaner than an Amy Grant Christmas album? It was affirmation of a core civic instinct: better the flawed character we know than the polished Shortsville, N.Y., carpetbagger we don’t. (The carpetbagger looked a lot more appealing four years later, when Bredesen ultimately was elected mayor in the wake of peak Boner mortification.)
That kind of devil-you-know impulse depends on a kind of scale that’s in Nashville’s rearview mirror.
When Boner was elected, Nashville was a city of fewer than a half-million people (where my rent was $300 a month). Today more than 700,000 people live in Davidson County — and more than 2 million in the total metropolitan area. The city that once drew a few million annual tourists now hosts something like 15 million. The economy has expanded to something unrecognizable, powered by industries that barely had a foothold in Music City in the early 1990s. You can’t run a place like that on a sense of intimacy.
The Nashville that made Boner possible was full of colorful people like him — politicians, bar owners, contractors, minor celebrities. Figures whose reputations arrived in the room before they did and held sway over the hearts and minds of voters for many decades, in some cases.
It doesn’t take a skyline full of cranes to make clear that version of Nashville is long gone.
Today the Nashville that O’Connell leads is bigger and richer. And yes, more prosperity means higher property taxes and higher rents. It is also far more invested than in decades past in how it chooses to present itself and how the rest of the world sees it. It doesn’t want to give off a whiff of hometown hick.
And yet the choice of O’Connell suggests something else too: that Nashville hasn’t

entirely given up on the idea of itself. He’s a local in a way Nashville largely didn’t elect after Boner — that is to say, born and raised — and his politics of stadium skepticism and resistance to growth at any cost suggest a version of civic identity that is pivotal, moral, critical to Nashville’s evolution. (Yes, to the probable delight of Nashville native and former Mayor David Briley, we’re ignoring fellow townie Mayor John Cooper as an outlier data point.)
The fact that both O’Connell and Boner are Nashville-made is where the similarity ends. O’Connell is a much more refined version of local boy — the MBA and Brown pedigree (but the son of a teacher and civil servant, not hailing from the blue-blood class), existing on a plane adjacent to but not fully a part of the monied caste.
I live in Bangkok now, and have for long enough that Nashville sometimes comes into focus differently from a distance. Somewhere between icepocalypses and ribbon cuttings, the city has become simultaneously easier to explain and harder to recognize. Watching the last mayoral race from afar, it seemed clear to me that O’Connell was the candidate who felt most genuinely of the city — not just positioned to run it, but actually shaped by it. And in all the ways that mattered most (read: politically courageous), he was unlike his opponents.
Still, Nashville’s insularity has evaporated, and it has become a place that needs leaders who can survive scrutiny. That means being less wonderfully weird (though we can always hang onto the era when O’Connell bought Daryl Hannah’s El Camino). The tradeoff is obvious and can’t be overlooked just to humor a little nostalgia. The city’s economy is broader, its reach farther, and its influence now global.
Meanwhile, like the city he led, Boner’s long gone, having settled down the road a piece in Franklin more than 20 years ago to teach social studies at Franklin High School.
The city didn’t just move on from him. It outgrew the version of itself that would have understood him — and when it came down to it, forgiven him. ▼
Metro Human Relations Commission is evaluating how accessible Metro departments are to those not fluent in English
BY ALEJANDRO RAMIREZ
ON SATURDAY, the Metro Human Relations Commission launched a survey that the body hopes will offer insight into how speakers of different languages are able to access public services in Nashville. The survey is part of a broad study evaluating language access across Metro departments and the barriers facing Nashvillians who don’t speak fluent English.
“We want to understand what their experience has been like with accessing Metro Nashville services, specifically in a language other than English, so that we can deliver services at a high-quality level to everyone,” says Gavin Crowell-Williamson, a research analyst and Title VI coordinator with the Metro Human Relations Commission.
The survey represents phase two of the Metro-wide language access assessment. The first focused on Metro departments — collecting data on their translation services, reviewing related policies and conducting self-assessments. Now the focus is on everyday Nashvillians who need help from those departments.
MHRC has been working with community organizations like Tennessee Immigrant and Refugee Rights Coalition, Conexión Américas and others while designing the study, and those partners will be vital to raising awareness about the survey.
The survey will be available in 10 languages: Spanish, Arabic, Burmese, Chinese, Nepali, Somali, Tagalog, Vietnamese, English and three Kurdish dialects.
The survey will be available online, but Crowell-Williamson says MHRC plans to work with community partners to distribute flyers and even physical copies of the survey at pop-up events and at their facilities.
The survey is not time-limited, and will instead conclude when MHRC reps feel they have an adequate number of responses that accurately reflect the number of Nashvillians who speak a language other than English.
Crowell-Williamson says language access is about more than just translation. “We’re also trying to think broader than that,” he says. “How can departments be more proactive about language services, so that from the moment you go to whatever department’s website, they already have documents translated, they already have tools so that you don’t have to go through an extra layer that an English-speaking person wouldn’t.”
Emergencies like January’s ice storm demonstrate the value of making information available in multiple languages: Spanish-speaking community groups like The ReMix Way provided
“
“WE WANT TO UNDERSTAND WHAT THEIR EXPERIENCE HAS BEEN LIKE WITH ACCESSING METRO NASHVILLE SERVICES, SPECIFICALLY IN A LANGUAGE OTHER THAN ENGLISH, SO THAT WE CAN DELIVER SERVICES AT A HIGHQUALITY LEVEL TO EVERYONE.”
— GAVIN CROWELLWILLIAMSON, METRO HUMAN
RELATIONS
COMMISSION
resources to families in need, for example. Crowell-Williamson agrees that “events like Winter Storm Fern highlight the importance of the work.” But he also emphasizes that language access has been a “long-standing priority of our department.”
MHRC released a 2017 report that laid the foundation for the current study and stressed the importance of the work as Nashville’s immigrant populations grew. That report found that more than 75 percent of departments “interact with linguistic minorities and most are receiving requests for language assistance,” but only 35 percent of departments “have a language access coordinator and less than 30 percent have a system in place to track language assistance services.”
They also launched a language access pilot program in 2023 with the Tennessee Language Center, which partnered with MHRC and five other Metro departments. In 2024, the TLC reported it provided 6,107 minutes of interpreting services in 11 languages, created four new language access plans and “provided live interpretation for the mayor’s State of Metro address for the first time in Nashville’s history.”
Following presentations by MHRC to the Metro Council Immigrant Caucus and to Metro department heads in 2024, Mayor Freddie O’Connell allocated dedicated funds to the current language access study and to the creation of Crowell-Williamson’s role.
“It’s our department’s belief that one’s fluency in English should not be the determining factor in accessing government services, whether that is storm-related services ... or receiving health care, reporting a crime, enrolling a child in school,” says Crowell-Williamson. “Language access is not a luxury. Especially now, it’s a critical component and necessity for Metro Nashville, and that idea is really what is the impetus for this study.”
The survey is available in multiple languages at nashville.gov/departments/human-relations/ research-projects/language-access. ▼

















From platinum-selling chart-toppers to underground , household names to undiscovered gems, Chief’s Neon Steeple is committed to bringing the very best national and regional talent back to Broadway.









Brinley Addington, Jerry Flowers, Jordan Walker
&
4.19 Dixieland Delight: Hotter Than a Hoochie Coochie 90s Country Tribute
4.21 Buddy’s Place Writer’s Round w/ Preston James, Meg McRee, Patrick Murphy
4.22 Adam Hood, John Baumann
4.23 Flat River Band
4.24 Melodies For Miracles: A Benefit for St. Jude Children’s Research Hospital w/ George James, Chloe Lawson, Shelby Lee Lowe, John Pate, Dan Minogue, Sofia Nargentino, Tae Wright
4.25 Jeff Hyde
4.30 Bryan White
McBryde: Mixtape From The Mixed Up Years SOLD OUT
At Chief’s we understand that great music is born from the heart and soul of it’s creators, which is why our writers’ rounds are dedicated to celebrating the brilliant minds behind some of today’s most iconic songs.









APRIL 3 - MAY 29
SIDEWALK SESSIONS FREE LIVE MUSIC ON PNC PLAZA
APRIL 8
BRELAND & FRIENDS
BENEFITING OASIS CENTER WITH ASHLEY COOKE, DASHA, PINK SWEAT$, DURAND BERNARR, K. MICHELLE, KAITLIN BUTTS AND WALKER HAYES
APRIL 9-19
NASHVILLE COMEDY FESTIVAL
FEATURING MORGAN JAY, SAL VULCANO, SHXTSNGIGS, HEATHER MCMAHAN, JOEY DIAZ & MORE
MAY 2
JOSH RITTER

JULY 9
HARRY CONNICK JR. ON SALE FRIDAY AT 10 AM
AUGUST 13
GLADYS KNIGHT ON SALE FRIDAY AT 10 AM
MAR 21 & 22, 2027 LIVE AT THE OPRY HOUSE CECE WINANS ON SALE MONDAY AT 10 AM

AsTheBoringCompany’s Music City Loop tunnels forward, we explore thecompany ’ s trackrecord,thetunnel’s environmental impac t and the politics surroundingtheproject

IN JULY, billionaire Elon Musk’s The Boring Company announced a plan to build a parallel pair of 9.5-mile-long underground tunnels stretching from the Nashville International Airport to the downtown core.
The Boring Company says the loop will be able to transport between 20,000 and 30,000 people per hour via Tesla vehicles. The company also says the project will remain privately funded, and that its leaders hope to construct stations throughout the city and expand the system in coming years. Despite protests from Nashvillians, safety and environmental concerns raised by the Metro Council, and reports of construction crews walking off the loop construction site in November, the project is moving forward at a rapid pace — thanks to support from state leaders. During a livestream late last year on social media platform X (also owned by Musk), The Boring Company president Steve Davis called the tunnels “amazingly safe.” “It is by far the safest public transport system out there,” he said.
In this week’s three-part Scene cover package, we explore The Boring Company’s track record, talk to a geoscientist about the Music City Loop’s environmental impact, and dig into the politics surrounding the whole thing.


State vs. Metro power struggle persists as state and local leaders fight for control over tunnel project
BY JULIANNE AKERS
A MIX OF LEADERS gathered at the Nashville International Airport in July of last year for a press conference, where The Boring Company made its formal announcement introducing the Music City Loop tunnel project. Those in attendance included Gov. Bill Lee, Metro Nashville Airport Authority CEO Doug Kreulen, officials with The Boring Company, local business and hospitality professionals, and even U.S. Transportation Secretary Sean Duffy.
But largely absent from that press conference were key Metro leaders, including Mayor Freddie O’Connell. When state Rep. Justin Jones (D-Nashville) tried to enter the event, he was denied entry, being told it was a private event requiring an RSVP.
For many state Democrats and local officials, this was the first sign that there would be issues with transparency and communication surrounding the project.
“I just knew it was already gonna be a contentious fight,” state Sen. Charlane Oliver (D-Nashville) tells the Scene. She says she first found out about the press conference several hours before it was set to begin and heard the official announcement through the news.
At-Large Metro Councilmember Delishia Porterfield tells the Scene she also first got word about the announcement of the Music City Loop via news reports.
“Because we were only hearing about it from the media, we were very limited in the information that we had,” Porterfield says. “It was very frustrating to learn about a project that’s going to be in your city and the city that you govern and not having the appropriate information to be able to share with residents.”
In the eight months since the project was announced, many state Democrats and Metro leaders have made it clear that they oppose the project, citing a host of concerns related to public safety, the environment, accessibility and impacts on the city’s infrastructure. Some councilmembers have also referenced The Boring Company’s track record of ghosting cities and backing out of proposed tunnel projects.
Oliver and Porterfield hosted a town hall event in March outlining many of these worries and taking a firm stance against the project. The next day, the Metro Council passed a symbolic resolution opposing the tunnel. Oliver sponsored a resolution at the state level expressing opposition to the project, but it failed in committee due to lack of Republican support.
In February, The Boring Company met with councilmembers during a public Transportation and Infrastructure Committee meeting where
company reps were grilled on a range of topics, including the tunnel’s impact on traffic and roads, water quality and emergency response measures. Following that meeting, many councilmembers felt their questions remained unanswered and that the responses they did get were vague.
The mayor’s office first had conversations with The Boring Company about the potential for a tunnel in spring 2024, though they distanced themselves from the project following voters’ approval of Mayor O’Connell’s Choose How You Move transit referendum that fall. The referendum’s 2-to-1 passage coincided with the reelection of President Donald Trump, who quickly made Elon Musk, owner of The Boring Company, a close political ally.
In September 2025, the mayor’s office sent The Boring Company a list of nearly 80 questions about the Music City Loop, to which The Boring Company responded with an 18-page document only partially answering the inquiries.
Despite local pushback, The Boring Company has plowed forward with the project. Having secured an agreement with the Metro Nashville Airport Authority, and with the current tunnel route set to run underneath state-owned roads, The Boring Company has been able to essentially skirt the need for permits or approvals from Metro. Now state Republicans — who view the project as an economic driver for the state — are working to further cement their control over the project.
State Senate Majority Leader Jack Johnson (R-Franklin) is sponsoring the “Subterranean Transportation Infrastructure Coordination Act,” legislation that would create two state-run governmental entities wielding most of the oversight over the Music City Loop. This would include the Governor’s Infrastructure Coordination Council, to be composed of commissioners from state departments. The bill would also create the Subterranean Transportation Infrastructure Coordination Authority, which would be made up of members appointed by the governor and speakers of the House and Senate. The authority would be responsible for resolving disputes and hearing appeals that may arise when it comes to constructing the project, and would hold the power to condemn publicly owned land.
Oliver and Porterfield see the bill as another form of overreach by the state legislature, which has made previous attempts at targeting Nashville’s local government — including legislation to cut the size of the Metro Council in half. (That case is currently looming in the Tennessee Supreme Court.)
“It just feels like they’re trying to paint a picture with watercolors,” Oliver says. “You know, when you paint with watercolors, it bleeds outside the lines just a little bit, right? And that’s the imagery that I get with this tunnel. They are not going to color a perfect line … in the way that realistically won’t touch any local property, private property. It just does not seem realistic.”
O’Connell told reporters on March 18 that he has concerns in regard to the pending state legislation.

“I’ll say for our part, anything that would disrupt our ability to have certainty about public utility infrastructure, in particular sometimes things that are related to surface transportation, those are all the things we’re going to be looking at,” O’Connell said.
Some Nashvillians have shown up to Metro Council meetings to speak out against the project, and some councilmembers and state lawmakers say they have heard constituent concerns. When asked about the council’s resolution opposing the project, Senate Majority Leader Johnson dismissed the idea that most people are against the Music City Loop.
“I was disappointed, and frankly, I don’t think it’s reflective of the general populace,” Johnson told reporters in March. “I think there’s a lot of enthusiasm for this particular project and what it could do long-term to improve our traffic congestion.”
This also appears to be the narrative being pushed by The Boring Company.
“We wouldn’t go into a city and fight to build something that’s so expensive and labor-intensive, and it’s just an incredibly difficult project,”
The Boring Company president Steve Davis said during a virtual town hall event hosted on the Musk-owned social media platform X in November. “We’re still going because everyone has been unbelievably positive.”
While there has been support expressed for the tunnel from local leaders in the hospitality and tourism industries, there’s been little evidence to show that a majority of Nashvillians are in favor of the project.
Because the state legislature is controlled by a Republican supermajority, and because Republicans are lockstep in their support of the project, there’s not much anyone can do to halt the progress of the tunnel. But as it continues to develop, legal action is one tactic its opponents may consider — whether it’s in response to the Music City Loop’s environmental impact, labor practices or potential safety concerns.
“I think [The Boring Company] chose the state of Tennessee specifically because they had the full backing of a Republican legislature and governor that will do anything that they want when asked,” Oliver says.
The Boring Company did not respond to the Scene’s requests for comment. ▼
A warning from a Las Vegas Loop critic: ‘Don’t take the bait’
BY NICK PIPITONE
FOR A PROJECT billing itself as “express public transportation,” little about The Boring Company’s proposed Music City Loop follows the traditional playbook. State officials, including Gov. Bill Lee, have promoted the tunneling project as fast, privately financed and built without taxpayer dollars. Critics argue that the framing may be misleading and question whether the proposed Loop project functions as public transit at all.
As Nashville residents weigh what the proposed Music City Loop could mean for the city, Las Vegas provides the only operational, realworld preview. The Vegas Loop, which opened in 2021, is a network of underground tunnels that transports passengers between the Las Vegas Convention Center and nearby hotels using Tesla Model Y vehicles. Construction began in 2019, and the system currently includes eight stations, with roughly 15 more expected to be built in the coming months, according to Boring. The company still has much more work to do. The Vegas Loop has been approved for a sprawling 68-mile network with 104 stations. Boring says that, if that ambitious goal is ever met, it would become the second-largest tunnel transportation system in the U.S., behind only the New York City subway system.
The company claims the Vegas project has “already transported more than 3 million passengers,” and “in its final form, the Vegas Loop will serve up to 90,000 passengers per hour.” The Vegas Loop’s real-world performance is far more limited than its long-term projections. At peak, the company claims it has demonstrated a throughput of about 4,400 to 4,500 passengers per hour. During large conventions, it can move roughly 30,000 passengers per day. While Boring projects a much higher capacity for a fully built
network, the existing system shows that as of now, the Vegas Loop operates at a scale closer to buses or a high-frequency shuttle system than to traditional mass transit like light rail. This relatively low passenger capacity is one reason why Ben Leffel, an assistant professor of public policy at the University of Nevada, Las Vegas, has emerged as an outspoken critic of the Vegas Loop.
“In and of itself, it is better than nothing in terms of a transit option,” Leffel tells the Scene “But it should never be confused as a substitute for public transportation.”
Despite criticism, cities across the U.S. and abroad continue to express interest in Boring. The company announced plans for a Dubai Loop in early 2025, signaling its ambitions to expand internationally. But the company’s track record is erratic at best. Since 2017, The Boring Company — founded and owned by billionaire Elon Musk — has pitched projects in Washington, D.C.; Baltimore; Chicago; Los Angeles; San Jose, Calif.; San Antonio, Texas; Miami; and Australia, to name a few. None of those proposals ultimately moved forward, falling apart at various stages, sometimes for unusual reasons. In 2022, Bexar County, Texas, selected Boring to build a transit link between downtown San Antonio and the San Antonio International Airport. After Boring won the bid, the Alamo Regional Mobility Authority entered into a development agreement to study the project’s feasibility. But the process stalled soon after. Officials say the company never responded to the agreement, and follow-up calls went unanswered. Reggie Fountain, operations engineer for the Alamo RMA, told the San Antonio Report last year, “They just kind of ghosted us. So we essentially just assumed that it was dead and didn’t move further with it.”
Much of the company’s publicity is supercharged by X, the social media platform also owned by Musk, which promotes its projects and engages directly with followers. Boring (@ boringcompany) has 1.1 million followers on X, and its posts regularly draw high engagement with videos of in-progress tunneling in Las Vegas and Nashville. One of its more unconventional outreach efforts was the “Tunnel Vision” competition, which invited the public to submit proposals for a one-mile tunnel in their own communities.
In Knoxville, that approach created an awkward situation for the city government. The company selected a proposal from a local small-business owner as a contest finalist. But a city spokesperson said Knoxville Mayor Indya Kincannon and the city administration had no involvement with the application.
Kacee Leekley — a resident of Sweetwater, Tenn., and owner of a web design firm — submitted the “Vol Loop” concept for a one-mile tunnel connecting Market Square in downtown Knoxville to the University of Tennessee campus. As the proposal gained visibility, Leekley reached out to local officials to gauge interest. He said Knox County Mayor Glenn Jacobs — the former WWE wrestler once known as Kane, and a current Republican political insider — was supportive. But Leekley’s experience with Knoxville’s city
leadership was far less encouraging. “One thing I learned very quickly is that there’s a lot of politics involved in stuff like this,” Leekley tells the Scene
The Boring Company’s website lists a range of projects in various stages of development, some of which sound like science-fiction.
“IN AND OF ITSELF, IT IS BETTER THAN NOTHING IN TERMS OF A TRANSIT OPTION. BUT IT SHOULD NEVER BE CONFUSED AS A SUBSTITUTE FOR PUBLIC TRANSPORTATION.”
One is a proposed “Hyperloop” near Bastrop, Texas, where the company says passengers could travel in autonomous electric pods at speeds exceeding 600 mph. The company says a test track is already complete and in use, and notes that it partnered with SpaceX — another of Musk’s ventures — to host four student competitions. The company claims prototype pods reached speeds of up to 288 mph. Beyond infrastructure, the company has also ventured into consumer products, including a $500 flamethrower that is now sold out. When The Boring Company launched in 2018, CNBC reported that the company sold $3.5 million worth of the product in a matter of days.
The company’s strange behavior and track record raise a larger question: Why would a state government like Tennessee trust The Boring Company for a critical public infrastructure project? Leffel, the UNLV professor, says the appeal is driven by “the illusion of tech innovation” and the lower upfront cost compared to more proven systems like light rail. “Elon Musk is selling a false image of what transit should look like, similar to the way Henry Ford once framed cars as freedom,” Leffel argues.
While Loop projects may generate excitement among Musk devotees, Leffel cautions that cities should take a measured approach to the privately funded proposals. “My message would be simple,” he says. “Don’t take the bait.” ▼
Professor Mark Abolins talks about Nashville’s challenging bedrock
BY ALEJANDRO RAMIREZ
MANY QUESTIONS WENT through Nashvillians’ minds when Elon Musk’s The Boring Company announced plans for the Music City Loop — a tunnel from downtown to the airport serviced only by Tesla vehicles. Chief among them: “Is that safe?”
Nashville’s limestone bedrock is susceptible to forming sinkholes, and the 2015 “Nashville Next” report declared building a subterranean subway “cost-prohibitive” due to the city’s geology. So letting a private entity loose
underground seemed unwise — especially when the company racked up almost 800 environmental violations for its Tesla tunnel in Las Vegas. (And you can get into the politics of this project elsewhere in this cover package.) The Boring Company hired an outside group to conduct an evaluation of the project and its environmental impact. The report was released in December but did little to satiate the skepticism of the Metro Council.
Middle Tennessee State University professor of geoscience Mark Abolins notes that engineers have surmounted similar geological challenges in countries like China and South Korea. But such projects are expensive. “Often it comes down to the economics you’re dealing with,” Abolins tells the Scene. “Engineers can design to overcome all sorts of challenging situations, but then actually building out what they’re designing and planning — that requires a certain amount of money.”
The Scene spoke with the MTSU professor about the challenges of working with Nashville’s limestone bedrock and what other information he’d like The Boring Company to make available. The following has been edited for length and clarity.
What was your reaction to the initial announcement about the Music City Loop? I was probably a little surprised. “Wow — big project potentially happening in Nashville.” I am a geoscientist, so of course my interest was piqued. I started wondering, “How is this going to work? How are they going to design for the geology that we have around here?”
The Boring Company has been criticized about their lack of transparency, communicating mostly through their own website and press releases. Were they addressing your concerns throughout that process? They have not put out a huge amount of information. … The first release of meaningful information to me as a technical person came in December when the environmental impact work by people external to The Boring Company was made public, and that allowed me and others to learn a little bit more about what they’re actually doing to make this work in this area.
And what did you think of that December report? It has a lot in it that is what I would expect to be in it. For example, The Boring Company is using very sophisticated seismic techniques to look underground at the geology along the tunnel route. They’re also doing a lot of test drilling along the route, and they’re taking advantage of drilling [and] coring that’s been done by others in the past, so all of that was very much in line with what I would expect. And some of the details, like the seismic techniques that send vibrations down into the ground and allow engineers to get essentially sort of like an ultrasound of the earth. … Those sorts of details were in the
information that came to light in December, as well as plans to divert water away from the tunnel at the surface, and also, as best as they can, to seal the tunnel using grout and other materials to keep water out of the tunnel, and also to keep anything that’s in the tunnel out of the surrounding environment.
Was there anything that left you wanting, or that you still wish had been addressed? No, the report is very general. It does contain some technical detail. …. But there’s a lot more that they’re doing that they’re not going to make public.
Speaking of challenges, a lot of people bring up limestone. It’s the limestone. Yeah, that’s exactly it. This kind of rock, which is likely to be encountered along parts of the tunnel route — it gets water in it. It has cracks in it. Naturally, water gets in the cracks, and it hollows out the limestone — has hollowed out the limestone over long amounts of time — resulting in fissures through which water can move. There’s some potential to encounter caves along the route. Tennessee has more caves than any other American state. That said, Davidson County would be one of the places where there are fewer caves, as opposed to other places — say, the Cumberland Plateau. …
[It’s] especially important when you’re dealing with limestone to use grout and other materials to seal the tunnel, keep water out of the tunnel, keep what’s in the tunnel out of the surrounding environment. … With limestone, you have potential for subsidence, for the ground surface to go down, potentially forming sinkholes. And over long amounts of time that has happened in the Nashville area.
Is there any information you’re particularly interested in seeing come out next from the company? It would be great to know [if] they are able to do any sort of environmental testing inside the tunnel demonstrating that water is not coming in; environmental testing in the surrounding area, to demonstrate that anything involved in construction of the tunnel is not getting into the surrounding environment. … If they’re able to make some measurements of the ground surface along the tunnel route and make that sort of information available to the public, that would again address some of these concerns that people have. And just more information about the geology that they’re encountering as they work their way through the subsurface; to the extent that they can make that public, that would probably be helpful as well.
In terms of the level of information that has not been made available, is this unusual? Or is this common for projects of this kind of magnitude? That’s difficult to gauge. Different projects have taken different approaches. Certainly, this one is very proprietary. They’ve released a relatively small amount of information, and I think that’s been very vexing to members of the Nashville city council, for example, and some residents … And while I can speak to this in relative terms like this project versus other projects, I would characterize this one as very proprietary, very, very private, only releasing the information that they have to release. At least thus far, that has been the approach they’ve taken, to a large extent. ▼

Name:
MEET





















































ART [TAKE ME TO THE RIVER] TAMARA REYNOLDS: MELUNGEON
The idea that the more particular the vision, the more universal its reach comes to mind when looking at Tamara Reynolds’ photographs. (James Joyce phrased it neatly: “In the particular is contained the universal.”) Reynolds’ portraits made in and around The Drake Motel, for example, are limited to a narrow geography and an even narrower set of circumstances, but the empathy she shares with her subjects turns them into familiar figures whom any viewer can identify with. Reynolds, who teaches photography at both Vanderbilt and Belmont universities, returns to this idea with her new series Melungeon, which captures life in the small town of Sneedville, Tenn. The exhibition, on view through June 26 at Begonia Labs, refers to Sneedville’s community of mixed-race people whose ancestry draws from African, Native American and European lineages. But the photographs here are far from exoticizing or othering in any way. Curator Grace Aneiza Ali explains this well in her exhibition statement: “Where we expect isolation, Reynolds’s images reveal relation. … At a moment when American identity fractures along imagined lines of purity, Melungeon reminds us that mixture — mélange — has long been our nation’s story.” The gallery is open Thursdays and Fridays from 4 to 7 p.m., on Saturdays from 1 to 4 p.m., or by appointment. LAURA HUTSON HUNTER
THROUGH JUNE 26 AT BEGONIA LABS
2805 WEST END AVE. Visit calendar.nashvillescene.com for more event listings
[PLEASURES OF THE FLESH] FLESHWATER
Fleshwater first appeared on my radar a year ago, warming up the stage for alternativemetal heroes Deftones at Bridgestone Arena. Judging by the packed floor, Chino Moreno and company’s fan base was already hip. The coed five-piece hails from the Merrimack Valley just north of Boston, a hot spot for intelligent hard rock dating back to Cave In, Converge and Piebald in the ’90s and Aughts — and like those acts, there’s a method to Fleshwater’s madness. Listening to the group’s latest, last year’s 2000: In Search of the Endless Sky, there’s no shortage of megaton, mosh-pit-worthy riffs, or martial, blunt-instrument drumming. But lead singer Marisa Shirar’s clear-eyed, soaring vocals go a long way toward inverting the more aggro, macho trappings of music of this ilk. Imagine a
fledgling Deftones sharing a practice-space wall with Björk’s turn-of-the-’90s band The Sugarcubes and — in lieu of scheduling practice at different times because of all the inevitable sound bleed — they simply form a supergroup. Since Exit/ In’s 2023 reopening, its marquee hasn’t featured many loud rock bands; Fleshwater should make for a nice change of pace. Gen-Z L.A. duo After — “Massive Attack meets Michelle Branch,” reads their self-penned bio — supports. The show is sold out.
CHARLIE ZAILLIAN
8 P.M. AT EXIT/IN
2208 ELLISTON PLACE
[TEACH YOUR CHILDREN]
FILM
Slide into Little League season by watching The Bad News Bears. Released in 1976, The Bad News Bears will need a few disclaimers for today’s younger audiences: Kids back then had access to cigs but not always seatbelts, for example. The film is a 1900s period piece, but Gen Alpha will like its commitment to underdog camaraderie and good ol’ cussing. What hits now is how many actual kids were on the field back then. In today’s youth-sports industry, there are often more grown-ups involved than there are kids. And unfortunately, not a single one of them is Walter Matthau. Playing an aging former minor leaguer coaching a team of misfits, he is perfectly cast opposite 13-year-old Tatum O’Neal —fresh off her Oscar-winning Paper Moon performance. Matthau understands his role is about interacting with kids as though they are adults. Makes you wonder … is this a kids’ movie or a movie for adults that happens to have kids in it? Now, 50 years after its original release, Bad News Bears will screen multiple times for one day only as part of Regal’s monthlong Legends of Laughs series. TOBY ROSE MULTIPLE SHOWTIMES AT LOCAL REGAL THEATERS
FILM
[YOU’RE A STAR] MIDNIGHT MOVIES: JOSIE AND THE PUSSYCATS
I’m continually fascinated — amused even — by the ongoing reappraisal of Josie and the Pussycats, the big-screen revival of the animated girl group both Archie Comics and Hanna-Barbera brought to life back in the day. Critics and audiences weren’t interested when it dropped 25 years ago this month. (At least we gave it a positive review.) I’m still kinda amazed writers-directors Harry Elfont and Deborah Kaplan (Can’t Hardly Wait) got the green light for this playfully balls-to-the-wall satire, in which the rock trio (played by then-young stars Rachael Leigh Cook, Rosario Dawson and Tara Reid) unwittingly takes part in a subliminal conspiracy cooked up by Alan Cumming and Parker Posey’s diabolical music execs. Released during the bubblegum-pop era it mercilessly mocked, this savvy, silly spoof of consumerism, media manipulation, celebrity culture and, of course, the greedy-ass music industry flew over a lot of heads. Thankfully, there’s a growing

cult of fans (a colleague of mine even made a Josie and the Podcats podcast) who applaud it for being the sort of high-camp, hella-meta, sneakily subversive gust of riot-grrrl power that would’ve made Manny Farber and Susan Sontag proud. Scene senior film critic Jason Shawhan will give a pre-screening intro. CRAIG D. LINDSEY MIDNIGHT AT THE BELCOURT 2102 BELCOURT AVE.
It’s hard to believe it’s been more than 30 years since Riverdance first took to the stage —originally presented as a seven-minute “interval act” during the intermission of the 1994 Eurovision Song Contest in Dublin. (Eurovision has since become something of a cultural phenomenon, now televised to more than 31 million people in 51 countries around the world.) You can catch the Riverdance spirit this weekend, as the Tennessee Performing Arts Center welcomes Riverdance 30 — The New Generation. The current U.S. tour certainly captures all the passion and precision of the original show, including Bill Whelan’s Grammy-winning score. But audiences can also look forward to plenty of updates, including fresh choreography, new costumes and visual elements and, yes, a whole “new generation” of performers. (Apparently, none of the current cast of dancers were even born when Riverdance first burst onto the scene.) Balancing traditional Irish music and dance with other iconic styles — including tap, flamenco and Eastern European folk — it’s a vibrant celebration of all things dance.
AMY STUMPFL
APRIL 3-4 AT TPAC’S JACKSON HALL 505 DEADERICK ST.
[IF YOUR CUP IS FULL, MAY IT BE AGAIN]
MUSIC
GILLIAN WELCH AND DAVID RAWLINGS: ACOUSTIC RECKONING
promises to be even bigger. Guests can look forward to sampling a wide range of dishes from more than 80 food vendors and food trucks, representing the cuisines of China, Japan, Korea, Thailand, Vietnam and more. More than 20 vendors will be on hand, highlighting colorful crafts, apparel, accessories and artisan goods. There will also be plenty of demonstrations and performances, showcasing everything from K-pop and lion dances to live music and theatrical programs. And of course, keep an eye out for panda-themed items and kid-friendly activities — from inflatables to face painting.
AMY STUMPFL
APRIL 3-5 AT FAIR PARK
2300 BRANSFORD AVE.
Even casual music fans probably know the Grateful Dead as the foundational jam band. But another aspect of the group doesn’t get talked about as much: how they wove acoustic blues, folk and country music into their rainbow tapestry of influences, earning a rightful place alongside other founders of what we’ve come to call Americana. That’s what roots-music royalty Gillian Welch and David Rawlings will honor when their Acoustic Reckoning Tour makes a hometown stop. The pair are marking the 45th anniversary of Reckoning, a compilation of acoustic performances from the Dead’s 1980 tour. The Reckoning track list includes Dead staples like “Dire Wolf” and “Cassidy” as well as general stone-cold classics like Elizabeth Cotten’s “Oh Babe It Ain’t No Lie” and “The Race Is On” as made famous by George Jones. “We have flirted with Grateful Dead music throughout our career,” Welch and Rawlings say in an Instagram post about a month after Dead co-frontman Bob Weir’s death in January, “until this anniversary was suggested as a good reason to book these shows. We know the Dead’s music is a mountain, and we’re hoping to start up from base camp this spring in celebration of their legacy.” Expect the selections you know from the double LP plus other surprises from the vast Dead repertoire.
STEPHEN TRAGESER
8 P.M. APRIL 3-4 AT BROOKLYN BOWL
925 THIRD AVE. N.
One of the nation’s fastest-growing Asian food and culture festivals is returning to Nashville this weekend, offering a host of traditional treats and themed activities. Panda Fest started out in New York City in 2024 and has quickly expanded to include celebrations in Orlando, Atlanta, Phoenix, Charlotte, Philadelphia, San Diego, Houston, Indianapolis and Boston. The festival marked its Nashville debut in 2025, and this year’s event
There are few better big-screen experiences than a Steven Spielberg blockbuster. The legendary director is being celebrated this month by the Belcourt with Weekend Classics: Spielberg, a sort of in-theater syllabus to prepare viewers for this summer’s UFO thriller Disclosure Day. Spielberg’s best tentpole extravaganzas — think Jaws, Raiders of the Lost Ark, E.T. — feel like they were scientifically designed in a lab to please packed crowds. Sweeping scores, gigantic vistas, perfectly engineered scripts, emotional payoffs — the films feature everything an audience wants out of a trip to the movies. Jurassic Park is one of the best examples. Every set piece is thrilling, every joke lands, and even the exposition is dished out in an entertaining way (shoutout to Mr. DNA!). The first view of the dinosaurs alone is worth the price of admission. I’ve seen Jurassic Park on the big screen, but only at a drive-in, so I’m eagerly anticipating hearing that John Williams music and those roaring creatures at the Belcourt. LOGAN BUTTS
APRIL 4 & 9 AT THE BELCOURT 2102 BELCOURT AVE.
If Charli XCX’s Brat is this decade’s defining party-girl album, Zara Larsson’s Midnight Sun is Brat’s sunnier little sister. Where Brat is Y2K-coded in a “Von Dutch trucker hat” way, Midnight Sun is Y2K-coded in a “Lisa Frank dancing dolphins Trapper Keeper meets Delia’s catalog meets Mandy Moore’s ‘Candy’ music video” way. Simply put, it’s a zillennial dreamscape of dance-pop perfection. Larsson isn’t new to the music scene; she released her debut international album So Good in 2017. But in pop-head parlance, Midnight Sun is the Swedish singer’s main pop-girl moment. It’s also one of the most fun and original pop albums in recent memory. Beyond the irresistible title track, the album features standout songs like the summer love anthem “Blue Moon,” the cheeky “Pretty Ugly” and the club banger “Hot






& Sexy,” which in another perfect nod to earlyAughts icons features reality-TV queen Tiffany “New York” Pollard. Larsson will bring her neverending summer to Marathon Music Works for the latest stop on her tour in support of Midnight Sun. Alt-pop artist and multi-instrumentalist Amelia Moore will open the show. BOBBIE JEAN SAWYER
8 P.M. AT MARATHON MUSIC WORKS
1402 CLINTON ST.
Nashville rock supergroup Million Dollar Emperors had planned to toast the release of their excellent eponymous debut album back on Jan. 29 with a performance in The Lounge at Eastside Bowl, but the icepocalypse forced them to postpone their celebration. Well, this Saturday the band will finally get to celebrate the album, which was released to all the major digital platforms on Jan. 17, with a show in The ’58 at the same venue. The record’s 10 tracks hit a sweet spot between classic British rock of the 1970s and Southern rock of that same era. Featuring five veterans of the Nashville rock scene — Joe Blanton (lead vocals, rhythm guitar, harmonica), Tim Carroll (lead guitar, vocals), Robert Logue (bass), Seth Timbs (keyboards, vocals) and Jonathan Bright (drums, vocals) — the group makes its experience evident in the accomplished songwriting and tight performances throughout the album. Even though they are the headliners, MDE will play the middle set of Saturday’s three-act bill, and they plan to perform the entire album in sequence. Timbs will kick off the evening with a set of material from his latest solo album Idle Hands, while punk- and power-pop-influenced Friend or Foe will close the show. DARYL SANDERS 7:30 P.M. AT THE ’58 AT EASTSIDE BOWL
1508A GALLATIN PIKE S., MADISON
FILM [MY GUARDIAN ANGEL FELL ASLEEP ON THE WATCH]
MOVIES: HEDWIG AND THE ANGRY
Not too long ago, I interviewed Hedwig and the Angry Inch writer/director/star John Cameron
Mitchell about his prized creation, which he originally developed off-Broadway with composer Stephen Trask before bringing it to the big screen in 2001. Mitchell told me he never made money with his musical story of a gay East German boy-turned-genderqueerrock-diva who sings about the “angry inch” she received during botched gender reassignment surgery. Nevertheless, it was a labor of love that still brought him so much more. “We did it for the purity of what we loved,” he said, “and it has brought me so many benefits emotionally, personally, more than anything I’ve ever made in my life. And it allowed me to do everything I care about.” He also believes that it might’ve inspired hetero moviegoers to see that “queerness is not that big a deal — and, in fact, can be rather fabulous, you know.” Saturday, drag/burlesque performer (and “invasive Southern species”) Virginia Creeper will introduce a fabulous midnight screening of the film at the Belcourt. CRAIG D. LINDSEY
MIDNIGHT AT THE BELCOURT 2102 BELCOURT AVE.
WILDLIFE
[VERY VERMIN] POSSUM PARTY: EASTER EXTRAVAGANZA
I’ve always been unashamedly pro-possum. Contrary to popular belief, they’re not especially likely to carry rabies, and they have a voracious appetite for ticks — helping limit the spread of Lyme disease. Plus, I think they’re cute. If you’re anything like me, or you’re looking for a less traditional way to spend your Easter Sunday, then you might be interested in this weekend’s Possum Party at The Basement. Hosted by local nonprofit wildlife rehab Vermin Sanctuary, the block-party-style event will feature live music from Kevin Scott and others along with vendors, food and critter-themed tattoos. Maybe we could even replace the Easter Bunny with the Easter Possum this year. Just an idea. Proceeds from the event will benefit Vermin Sanctuary, which not only rehabilitates possums but also helps out raccoons and other
vermin-like creatures before releasing them back into the wild. The nonprofit also has a hotline for wild animals that are found injured or orphaned. JULIANNE AKERS
4 P.M. AT THE BASEMENT
1604 EIGHTH AVE. S
HITS KEEP COMIN’]
Nashville singer and songwriter Jim Lauderdale has a music career that includes recording a 1979 album with bluegrass mandolinist Roland White that wasn’t released until 2018. Along the way, Lauderdale, who will be 69 in April, has put his name on a string of albums that includes the aforementioned collaboration with White and his 2011 full-length with Grateful Dead lyricist Robert Hunter, Reason and Rhyme. Lauderdale’s 2025 homage to 1960s country, Country Super Hits Volume 2, is one of the prolific countryAmericana auteur’s drollest efforts to date — he casts something titled “Artificial Intelligence” in a midtempo country shuffle. Like, say, fellow Nashvillian Joshua Hedley’s 2025 set of Westernswing-inflected country All Hat, Lauderdale’s new music has a light tone and a sense of humor. Country Super Hits is the kind of retro I can live with, and Lauderdale writes songs that sound like pastiches until you realize they’re getting through to you. Lauderdale also has a bluegrass album, The Birds Know, set for release in April. The April 6 show at Skinny Dennis continues his yearlong residency there, where he’ll play the first Monday of every month. He’ll be joined by The Game Changers, a crack band featuring guitarists Frank Rische and Craig Smith.
EDD HURT
7:30 P.M. AT SKINNY DENNIS 2635 GALLATIN PIKE
If there’s one film that encapsulates the purest form of visual storytelling, Koyaanisqatsi may be it. While its official genre may be documentary, director Godfrey Reggio’s masterwork certainly won’t be like any doc you’ve seen before. Many have called the film a “tone poem,” which does capture some of its mystique, but in truth, it’s a singular experience. What the film chooses to show may seem random at first: shots of American landscapes, sped-up footage of humans commuting through their city, intense close-ups of computer chips. It’s at once beautiful and chaotic thanks to legendary cinematographer Ron Fricke’s eye. Pay close enough attention, however, and the film’s story really opens up. Philip Glass’ iconic score acts almost as narration as it guides you through the film’s movements and climaxes. It’s one of those rare film experiences that somehow captures something bigger than itself. Is it an environmental warning? A lament on human progress? Just a really amazing montage? Find
out for yourself on April 6 at the Belcourt, with a special introduction from film poster artist Sam Smith. IAN MATTHEWS
8 P.M. AT THE BELCOURT
2102 BELCOURT AVE.
MUSIC [ROOTED]
R.O.O.T.S.: AN ALL-FEMALE ROOTS MUSIC JAM SESSION
The Culture at Large podcast is kicking off its first live performance event at Anzie Blue in Hillsboro Village. Journalist Marcus K. Dowling, creator of Culture at Large, unveils R.O.O.T.S.: An All-Female Roots Music Jam Session, featuring Bronwyn Keith-Hynes, Lilli Lewis and Jaelee Roberts. The idea is for R.O.O.T.S. to become a bimonthly event, highlighting the work of women in bluegrass, blues, Christian and folk, at one of the city’s women-owned music venues. Dowling notes that two-thirds of the Carter Family (who introduced country music as a commercial genre in 1927) were women. It’s past time to regularly appreciate and listen to women’s essential, continuing contributions to their genres. Tickets are free, but should be reserved online in advance. MARGARET LITTMAN
7 P.M. AT ANZIE BLUE
2111 BELCOURT AVE.
TV [IT IS HAPPENING AGAIN] TWIN PEAKS: SEASON 1
The moment in “Laura Palmer’s Theme” when the piano finally breaks into the synths is, for my money, one of the most beautiful chords in the world. There’s so much hope and despair in it, so much promise just before the song’s inexorable rise and fall — and the way Angelo Badalamenti puts the theme in conversation with the rest of the Twin Peaks soundtrack, from the main title to the “Love Theme,” is nothing short of masterful. Twin Peaks was recently made available for theatrical exhibition for the first time, and at the Belcourt’s ongoing marathon of Season 1, that soundtrack accompanies the show in theaters Wednesday nights in April. David Lynch’s work is often in conversation with film history and the screen as a medium, suiting the show perfectly for a big-screen engagement and a modern-day revisitation of its prescient themes of beauty and violence. After the 90-minute pilot, which screened in full April 1, episodes will be presented two at a time, consecutively and with a short intermission between each. Full-season passes are sold out, but tickets for individual nights are still available at belcourt.org.
ANNIE PARNELL
WEDNESDAYS IN APRIL AT THE BELCOURT
2102 BELCOURT AVE.































































































Grocery shopping your way through Green Hills? Make a night of it.
BY DANNY BONVISSUTO

Date Night is a multipart road map for everyone who wants a nice evening out, but has no time to plan it. It’s for people who want to do more than just go to one restaurant and call it a night. It’s for overwhelmed parents who don’t get out often; for friends who visit the same three restaurants because they’re too afraid to try someplace new; and for busy folks who keep forgetting all the places they’ve driven past, heard about, seen on social and said, “Let’s remember that place next time we go out.”
WHEN MY FAMILY and I left for spring break, there were only condiments and my emergency can of Canada Dry ginger ale in the fridge. For days I’d cobbled together a mishmash of meals, using up all the leftovers — or ’tovers, as my husband Dom annoyingly calls them, forming a backwards “c” with his right hand to make an air apostrophe — so we could return to a clean slate.
The downside of the clean slate is a long grocery list: I might as well have typed “buy everything” into the Google Doc we share for such things. In our house, I make the meal plan and grocery list and Dom shops — but I like to
go every once in a while to see what’s new and seasonal in the (I’m almost embarrassed to say) three grocery stores to which we hand hundreds of dollars every week. Most of the time, grocery shopping is a necessary evil. But with the right circumstances and mindset, it can be a surprisingly delightful (and productive) Date Night.
If Green Hills were a person, it’d be the kind of person who’s had every implant and form of plastic surgery, perhaps to the point of being unrecognizable. And GreenHouse would be the quiet inner beauty known only to those willing to look beyond the surface. Tucked in beside The Food Company on Bandywood, it’s the kind of place you could pass hundreds of times and never know existed.
If you’re unfamiliar with GreenHouse, let me be clear: It’s a bar in what was, decades ago, a working greenhouse. It’s not a house that’s green or a fun play on words like when college bars are named something like The Library. It is also one of the dreamier places to have a drink in all of Nashville. There are varieties of cacti and succulents on benches and shelves, in big pots
and small ones; orchids on the bar; branches jutting out from here and there, some wrapped with soft string lights; leafy vines of pothos, raspberry-colored bromeliads hanging from the ceiling in moss-covered bowls — and so much more, but that’s where my ability to identify plants ends.
At 5 p.m. on a Saturday, there was a nice flow of people, but GreenHouse hadn’t yet filled up to the point where we needed to stalk seats. This meant we had our choice of seating, from interior high-top tables to the bar to what feel like endless nooks and seating areas inside and on the front and back patios. I chose a high-top near the part of the bar where patrons order drinks and food. While Dom watched college basketball on the TV, I watched couples corralling little kids while having an early dinner (GreenHouse is all-ages until 8 p.m.); a large round table of parents and college-age kids having drinks and snacks; young women in maxi sundresses having a bridal shower or birthday party; a couple in Preds gear getting a pregame drink; and a woman at the bar with her big-eyed lap dog.
We took turns sharing sips of our Marley’s Par-
adise (rum, passionfruit and pineapple liqueurs) and Blood Orange Mezcal-ita (mezcal, blood orange liqueur, chile liqueur, lime juice) while making a plate piled high with bacon popcorn disappear quickly. Everyone knows you should never grocery shop on an empty stomach.
Say what you will about Green Hills — I have much to say when I’m stuck there in traffic — but it is convenient for big-box grocery shopping with Whole Foods, Trader Joe’s and Kroger within a few hundred feet of each other (even if you have to drive to and park at each one). Because I avoid the Whole Foods covered parking at all costs, we found a spot behind West Elm and first walked to Anthropologie to
GreenHouse 2211 Bandywood Drive greenhousenash.com
El Palenque 2210 Crestmoor Road, #2 elpalenquenashville.com

see if I needed a coir doormat in the shape of a farfalle pasta noodle, which of course I do, then whipped through Whole Foods. Despite two toothpicks of sample cheese cubes, we were hungry when we left but decided to hit Trader Joe’s before dinner since they close at 9 p.m.
Because there was still one more leg of our grocery list to finish, we needed a get-in-andget-out Date Night dinner. No lengthy description of the chef’s specials. No craft cocktails with fussy garnishes I have to remove in order to drink my drink. No amuse bouche.
Any time I suggest meeting someone at El Palenque, they either say, “Oh, I love that place,” or, “Where is that?” It’s been in the same blinkor-you’ll-miss-it strip of businesses on Crestmoor Avenue for 36 years, next to what used to be F. Scott’s Restaurant and Jazz Bar and what is now the Bank of Tennessee. More importantly, it’s one of three places to get Mexican food in Green Hills — and the only one that’s not a chain.
Chips, salsa and two waters arrived quickly, followed by a bowl of white queso, followed by our usual order: chicken chimichanga for Dom and enchiladas banderas (three rolls covered left to right with salsa verde, queso and ranchero
sauce in honor of the Mexican flag) for me. We wolfed it down while keeping one eye on a soccer game neither one of us cared about. At the host stand by the front door, I handed my credit card to the same man I’ve been handing it to for more than three decades, owner Jesus Medina, and for the millionth time Dom asked him to add a York Peppermint Patty to the total, even though he knows I detest the smell of chocolate mint. He does this to annoy me and you can’t convince me otherwise.
It was everything it needed to be.
I’m not going to pretend we had all the energy in the world to tackle our Kroger list after all that queso, but it was late enough that the store was gloriously devoid of people. This allowed us to practically sail through the aisles. Predictably, Dom said, “Do we need this?” while pointing at a bag of Froot Loops roughly the shape of a king-size bed pillow, and predictably I said we did not. I texted our teen from the ride home to help carry bags in the house, and predictably he said no — but was standing at the door when we arrived. This kind of Date Night doesn’t come with the same new-experience high that others sometimes do, but there is something low-key lovely about the rhythms of regular life. ▼


















































A
BY MADELEINE BRADFORD


WHAT DO BEANIE BABIES and reproductive rights have in common? A small, pink building on Gallatin Pike has the answer.
A Shop of Things is more than a trinket store — it’s a hub for Nashvillians who crave nostalgia and a spot for activist meet-ups and fundraisers. Monchhichis, bedazzled meme keychains and Heated Rivalry memorabilia fill the space. But cheeky political statements — often on stickers, buttons and hats — also demand attention.
These tchotchkes are emblazoned with proverbs like “Eat the Rich,” “Ain’t No Time for Fascists” and “Hotties for Abortion Access.”
“Products that are cutesy make the meaning feel a little bit easier to represent,” says shop buyer Sara Beth Pardue. Bright hues, bubbly text and familiar characters (everything from Calico Critters to Lizzie McGuire) enhance each tonguein-cheek message.
Owner Mia Calotta dreamt up A Shop of
femme accessories and blind-box figurines, the shop’s political pulse isn’t overshadowed. The escapist haven hosts fundraisers for reproductive rights, cannabis reform, animal welfare and LGBTQ health care.
It also provides community resources like flyers by 2025 Scene Nashvillians of the Year Music City MigraWatch, which give civilians instructions about what to do after spotting ICE agents.
Abortion Care Tennessee is a frequent event partner, providing educational resources and passing out Plan B pills — “Always a party,” says Toole. And when customers buy abortion-related merchandise, the shop donates part of the proceeds to the organization.
“We’re in a red state, and not always surrounded by like-minded people,” says Pardue. “[Events] bring not only money, which is important to these causes, but also a third place for people to go and exist.”
Staff members seek to cultivate a space focused on unity and actionable change — rather than cynicism and political weariness.
“It brings a sense of community and hope,” says Toole. “I think it’s so easy to fall into hopelessness and despair. Being in this space around people is like, ‘OK, cool, so I’m not fucking crazy.’”
Last year, A Shop of Things expanded into New York City’s Lower East Side with a location on Orchard Street. The NYC space has since been visited by celebrities like Lily Allen, Hunter Schafer and the Jonas Brothers. “The trinket culture is very strong up here, or just girlie culture,” says Toole.
Calotta recently moved back to New York — where she lived before moving to Nashville in 2016 — to oversee the store’s operations while still being actively involved with the Nashville storefront.
Things in college, where she and a friend started handmaking and selling trinkets and homewares in 2015. While Calotta initially started the practice as something fun to do on weekends, she “just kept making things, and people kept buying them.”
During the notable e-commerce boom spurred on by the COVID-19 pandemic, Calotta opened A Shop of Things’ brick-and-mortar in 2021. Now the store sells inventory from local artists and nationally loved brands like Baggu and Boy Smells. Guests can also purchase whimsical headshop fare from sister brand Burning Love.
“Our whole brand ethos is making everyday items cuter and fun,” says store manager Chelsea Toole. “It kind of goes into nostalgia, too. Walking around with a plushie on your bag is very nostalgic and cute.”
While being chock-full of eye-catching
“In Nashville, you don’t really have foot traffic, so people have to drive to their destination,” she says. “In New York, it’s in one of the hottest neighborhoods to walk around and shop, so people come in not knowing about the store at all. It’s kind of like a trap.”
One truth about the burgeoning trinket revolution: The ones who get it, get it.
“There was this podcast that these two guys did,” Toole says, laughing. “They called it a ‘millennial store.’ I don’t think it’s millennial just because we have nostalgic things. I think it’s more about girlhood — and we’re not discriminatory against anyone, so everyonehood.”









Fighter Fest: The Bridges for Parkinson’s Foundation featuring The Jim Brown Band, Sheryl Crow, Gary Chapman, Rich Gootee, Rob Harris, Mark D. Sanders, Bob Regan, Jack Sundrud & Fred Newell
WMOT Roots Radio Presents Finally Friday featuring Amy Speace, Essence & Gold Country + Thomm Jutz
Backstage Nashville! Daytime Hit Songwriters Show featuring Shawn Camp, Aaron Raitiere, Rob Williford & Aniston Pate + Gloria Anderson Monsters of Yacht -


Della Mae with Fancy Hagood
Bluebird on 3rd featuring Emily Shackelton, Victoria Banks & Phil Barton + Elaina Christina + Jerome Goosman
Time Jumpers
615 The Move Presents: NASHVILLE NIGHTS: The Live 80s revue featuring Jovan Bender, Nathan & Suzanne Young, Ronnie, Keesha Rainey, Nacole, Nick Connors, Royce Mosley, Kim Fleming, Jeremy Kelsey, Raquel Jackson, Joey Richey, Jannelle Means, Lashanda Evans & Kim Mont
Big Damn Music Jam featuring Colin Street, Noelle Toland, Christie Lenee, Jay Jones, Lucie Tiger & Chuck Thomas







































































































THERE’S A SPARKLE in Jessye DeSilva’s eyes when we meet over Zoom. Since her first single “Worry” in 2019, she’s transformed right before our eyes into a bewitching reveler of folk and Americana music laced with a deep, rich darkness. On her new album Glitter Up the Dark, out everywhere April 3, the Boston singer-songwriter conjures up odes about the queer experience. She searches through her own life for the light and dark, weaving them together into viney foliage, dressed with thorns and luscious petals. It’s as much about queer joy as it is queer pain.
DeSilva enlisted Aaron Lee Tasjan as her producer. Tasjan, whose cosmic country has made waves throughout Nashville and beyond, leaves his psychedelic fingerprints all over the album.
Opening cut “The Real,” featuring a guest vocal from Lafemmebear, radiates whimsy and grit, setting the stage for DeSilva’s strongest, most adventurous record to date.
“I knew that Aaron was often drawing from sound references that I wasn’t even totally into,” says DeSilva. “I wanted someone to both see my influences and honor them, but also to bring in stuff that I hadn’t even really dreamt of.”
Writing the record came during DeSilva’s personal breaking point. Unsure about her gender transition, she poured her heart and soul into songs such as “Forever in Drag” and “Life on Earth,” enlightening glimpses into human existence and the pressures of queerness. “I was just not ready to step into womanhood and acknowledge that part of me,” she says. “But I was also really struggling. I almost retreated into masculinity.”
When it was time to record, she had just come out as trans, having started hormone replacement therapy only a few months prior. You can hear a clear emotional shift in the way she phrases her lyrics and paints in brighter, more confident aural colors. “We’re all hurled into this world naked and afraid,” she sings with a sharp heaviness in “Forever in Drag,” a song that takes a deep dive into her journey to this moment. “We try on so many things for the sake of the parade.”
As bitter as it may seem, the song serves as a “meditation on the joy of owning the way that you present yourself, the way you adorn yourself,” she says, “but then also looking at that as armor in a lot of ways.”
In “Eldritch,” she grounds herself in Lovecraftian horror, including “the old ones that have been in the earth long before humans and Christianity,” she explains. “It’s terror that’s just simmering there.” The closing song, a progressive version of “Something Wicked” (which DeSilva previously released on her EP Hover), also harkens to folk horror through macabre strings that dig and scratch in search of primal strength.
“We are carried by the wind, and we will always
Jessye
BY BEE DELORES

be,” she howls. Adia Victoria and Butch Walker can be heard faintly ripping backing vocals to shreds, like two ghosts yearning for the afterlife.
DeSilva declares that she, and every queer person like her, isn’t going away anytime soon. Glitter Up the Dark arrives at a particularly tiring time for queer people. Among the many policies lobbied against the trans community, President Trump enacted a passport policy requiring all passports for transgender, nonbinary and intersex people to include only the gender signifier they were assigned at birth. The Supreme Court later granted the Trump administration a stay of the preliminary injunction in Orr v. Trump.
“I really struggled last year with the barrage of anti-trans [legislation] that happened after the inauguration,” DeSilva says with a sigh. “My
own passport was being held hostage by the State Department for six or seven months, and I pulled out of a tour with Aaron. I didn’t perform much last year. My relationship to the world feels painful and scary, and also filled with a lot of anger.
“But my relationship with myself and my sense of who I am and my everyday life are better than they’ve ever been, which feels very weird. I would rather be in a really good place at a really shitty time than in a really shitty place at a really shitty time.”
Jessye DeSilva walks in the footsteps of Stevie Nicks and Sheryl Crow with a cape flourish and deep admiration. You can find their influence — and that of artists like Tori Amos and ’90s establishment-crushing songwriters such as
Sarah McLachlan — all over the record. From the exuberant “Punk Rock Joy” to the guitar-bound hippy song “Fringe,” DeSilva masters the art of a fine-tuned craft. “Check your look, and get your ass out on the dance floor,” she sings with great force in the latter. Queer liberation comes in all forms, and sometimes what you really need is “a leather harness,” she sings with a wink you can practically hear. ▼
Playing 6 p.m. Friday, April 3, at The 5 Spot




Ibro Dioubate, Jeff Coffin and company get ready to bring the kinetic sound of West Africa to the Nashville Jazz Workshop
BY SEAN L. MALONEY




GET YOUR LISTENIN’ ears on and clear your schedule, because Friday’s celebration of West African music at the Nashville Jazz Workshop is going to demand all of your attention. Featuring a stacked lineup of in-demand local instrumentalists — centered on the collaboration of Djembefola Ibrahima “Ibro” Dioubate and saxophonist, educator and indie label head Jeff Coffin — the show is a dive into one of the world’s deepest musical wells.
music head over heels.
“There’s a lot of different Nashvilles,” explains Boyd. “When we go into different schools, between a Montessori and a private school and a public school and the inner city, you’re just going to have really different audiences. But everybody responds to the drum. Everybody responds to the music. It’s really universal because it’s the origins of [all of] our music.”
The band for Friday’s NJW performance underscores Boyd’s “a lot of different Nashvilles” point. Led by Coffin — who has performed with Béla Fleck and the Flecktones and Dave Matthews Band in addition to releasing more than 25 solo albums — the group features heavy hitters from the worlds of rock, jazz, pop and country.
BY JASON SHAWHAN
IT’S IMPOSSIBLE TO talk about Knoxville’s annual Big Ears Music Festival without acknowledging that it’s continually the most impressive gathering of artists, theorists and icons in the state. It competes on a nationwide level as well, but there’s something of a challenge in it for Nashville as Music City. But lest you think I’m trying to explore hateristic tendencies, there is a central paradox to what makes the liberating possibilities of Big Ears so overwhelming: Having all these venues so close together leads people to second-guess themselves, often abandoning shows after 10 or 15 minutes to see something else. It can be an absolute mukbang of FOMO. But in these current horrifying and agitated times, there’s something truly liberating about what an event like Big Ears offers. Each new set can be the ritual that grants a spiritual reset, even if just for a little bit. And most explicitly a ritual was Sō Percussion’s Sunday performance of Steve Reich’s Drumming, a 78-minute experience involving evolving percussive elements that, on conclusion, won a thunderous response from the crowd. It was as if an obstacle to enlightenment fell at the same time some miraculous sporting-event victory occurred. It was awesome, and it rewarded the shared durational aspect of the experience.



The event is organized by AfricaNashville, a nonprofit co-founded by Coffin and local dancer and artist manager Windship Boyd to bring African music to the schools and stages of Middle Tennessee. The gig is as much a celebration of music traditions that stretch back thousands of years as it is a statement about our future and the future of music.
The cross-cultural collab connects the most ancient and fundamental of human beliefs — namely, “drums are awesome” — to Nashville’s contemporary music scene.
“Listen, listen, listen, listen, practice, listen, practice,” Dioubate tells the Scene. He released his debut album Kossa Kassa on Coffin’s Ear Up Records last year. He is from a lineage of players that goes back generations, his family tasked with maintaining musical and oral storytelling traditions of his native Guinea that reach back to time immemorial. “Listen, practice, repeat. And then dance, dance … dance together, and sing too.”
It’s a musical pedagogy that stands in stark contrast to Western music education — raise your hand if you ever got kicked out of band class for fidgeting too much! But that’s exactly why it connects, why kids and adults fall for this
Keith Carlock has played drums with Steely Dan and Sting. Trumpeter Emmanuel Echem is a local mainstay who’s played with Kirk Franklin and Ivan Neville’s Dumpstafunk. Guitarist Bob Lanzetti has pushed fusion into the 21st century with Snarky Puppy. Nashville native Jon Estes has laid down the bottom end with Kacey Musgraves and Dolly Parton. And because you can never, ever have too many drums, Guinean drum maestro Fode Sylla rounds out the ensemble.
“It’s a music that unites — and to me, we need a lot more unity,” says Coffin. “And this music brings great joy. And I always tell my students, ‘Bring the joy when you’re getting ready to hit the stage.’ And Ibro and Windship and myself — and Fode and all the musicians, Keith and Bob and Jon — I think that we all have that similar spirit in that we want to uplift. We want to lift the bandstand and we want to bring the joy.”
While it may be a recent addition to the sound palette of Music City, this music has seen war and peace, famine and feast, hard times and good. It resonates with our times because it has transcended time.
“People really feel it,” says Boyd. “It’s amazing. It doesn’t matter if we’re at the Girl Scouts in Franklin, or the Country Music Hall of Fame. It doesn’t matter where we are, people feel it. And that’s why it’s so powerful.” ▼
Similarly, the legendary Blind Boys of Alabama (hands up from anyone who saw their remarkable Belcourt show in 2002) stepped up for a proper Palm Sunday musical revue and church service, with testifying, sing-along sections and those incredible voices and harmonies. Now a vocal trio, these gentlemen work hard onstage to deliver the frisson of sacred music in a soulful, rocking context, and it’s still quite a transformative moment. It doesn’t matter how many times you’ve heard their incredible take on “Amazing Grace” using the arrangement of “House of the Rising Sun,” you still feel that in your spine when they sing.
For 10 hours on Saturday (I was there for six of them), the Chicago-based minifestival Ragamala set up shop at St. John’s Episcopal Cathedral, and it was bliss. Working to bring Carnatic and Hindustani classical music to more mainstream domestic attention, this was an assortment of musicians and teachers playing with joy and technical wizardry. They may not have seen themselves as educators, but honestly, I learned more about the evolution of musical instruments and time signatures in this one day than at any previous point in my life. Opening with Kunal Gunjal on the santoor (a 100-stringed Indian ancestor of the hammered dulcimer) and the tireless Praveen Narayan on tabla (he would play tabla for the first three sets), the performance started with the Hindustani tradition, and it was just beautiful. The santoor is quite an instrument, and it feels soothing and mellifluous — the breeze and the brook. Next up was Saraswathi Ranganathan playing

the saraswati veeṇa (and yes, she was named for it). The saraswati veeṇa is, as she called it, “the great-great-great-great-grandmother of the sitar,” and it is one of those intimidating musical instruments that you can’t help but respect — if only for the back and upper-arm strength its mastery requires. We were also introduced to percussionist Swaminathan Selvaganesh (who was going to be working his ass off for pretty much the rest of the day, like Narayan), working with Narayan on tabla again. The trio was having a blast, weaving a sound that was alluring and evocative and emotionally freeing, contrasting beautifully with the opening santoor set.
The third set involved Ranganathan dipping out, with legendary kanjira player Selvaganesh Vinayakram taking point position alongside his son Swaminathan and Narayan. The kanjira is like a stealth tambourine, capable of much more precision and nuance. But in addition to that, Vinayakram is also a master of konnakol, a style of vocal percussion. (He compared it to beatboxing.) This was when the vibe shifted into kinesis and learning, because not only did he get an entire sanctuary full of people synced up to some incredibly complex time signatures, but there was palpable joy on his face as we all committed to the experience.
After stepping out for Perfume Genius’ set (more on that in a bit), I returned for the Ragamala grand finale, where Vinayakram and Selvaganesh were joined by the legendary Shankar Lakshminarayana, a major figure in world music for 60 years now (and also well-respected in this house for his work with Wendy & Lisa for the show Heroes). Shankar is an innovator of the violin, having crafted the “LSD” (L. Shankar Double Violin), a fascinating instrument that found a whole new language for blending the string and the synth.
But speaking of violin innovation, one has to give a shoutout to performance art icon Laurie Anderson, who had several performances and experiences available at Big Ears 2026. She presented a piece called “What War Is This? What Time Is It?” Like Christopher Walken and William Shatner, Anderson is an artist who can be identified by cadence, and she has used that gift to give voice to the thoughts that proliferate throughout the modern mind. I find her work soothing and sometimes scabrous, and I love her stories. (There’s a particularly staggering JFK tale here.)
If I have some misgivings about her experiments with AI, know that it’s the technology itself that unnerves, not what she uses it for. But would it be a proper music festival without some form of controversy?
A similar tech marvel, Reggie Watts took the stage at the Knoxville Civic Coliseum surrounded by several instruments and a beloved sampler/ sequencer rig, and proceeded to craft an improvised musical-comedy set that worked. Unless you’re in the jazz trance, “fully improvised” can be a warning. But Watts, a musical and comedic polymath, was enthralling. With such a broad swath of musical knowledge and ability, he was leaping genres and characters with the greatest of ease. Personal faves include The Oak Ridge Boys’ lighting designer, the music festival historian and his joy at playing in Tennessee, “one of the more symmetrical states.” Watts really is a must-see, for covering so much ground and managing to feel diaphanous but also informative. There’s something I find deeply encouraging when queer artists rock audiences on their own terms. And Mike Hadreas set up shop and gave the crowd an intimate set that nonetheless rocked very hard, delivering multiple simultaneous modes of experience and deploying that voice with control and passion. Joking about trying to improvise a Xanax for the sober, and summoning the exact right amount of drama, Hadreas’ Perfume Genius was exactly the right performance. He served up a rock show that delivered on traditional expectations but also something more focused on big emotions and vibes — and that includes the punishing strobes toward the end.
The emotional highlight happened early and hit hard, with the opening-night set from once and future TV on the Radio frontman Tunde Adebimpe, digging into much of his 2025 solo album Thee Black Boltz. Performing with just a boom box and a sequencer, Adebimpe brought intense and clarifying focus to the emotions that record is steeped in, with the occasional moment of between-song explanation or clarification. Adebimpe’s voice is an incredible instrument (watch out for the powerful, Princely falsetto he can deploy), and in his all-too-brief 45-minute set, he took The Mill & Mine on quite the journey. There are a lot of artists who can perform sincerity for maximum audience effect, but Adebimpe embodies sincerity rather than performing it, and you feel that in a way that stays with you. ▼




Saturday, April 4
SONGWRITER SESSION Steve Dorff
NOON · FORD THEATER
Saturday, April 11
SONGWRITER SESSION Joybeth Taylor
NOON · FORD THEATER
Saturday, April 11
BOOK TALK
Jimmy McDonough
Gary Stewart: I Am from the Honky-Tonks 2:30 pm · FORD THEATER
Saturday, April 11
HATCH SHOW PRINT Block Party
3:00 pm and 6:00 pm
HATCH SHOW PRINT SHOP
Sunday, April 12 HATCH SHOW PRINT Family Block Party 10:00 am HATCH SHOW PRINT SHOP
Sunday, April 12
MUSICIAN SPOTLIGHT Jason Wilber 1:00 pm · FORD THEATER
Wednesday, April 15 PANEL DISCUSSION
The Opry’s Comedy Tradition with Henry Cho and Gary Mule Deer 2:30 pm · FORD THEATER
Saturday, April 18
SONGWRITER SESSION Wyatt McCubbin NOON · FORD THEATER
WITNESS HISTORY
Locals Kids Always Visit Free Plan a trip to the Museum! Local youth 18 and under who are residents of Nashville-Davidson and bordering counties always visit free, plus 25% off admission for up to two accompanying adults.












Christian Petzold’s Miroirs No. 3 is the sort of family drama we don’t see enough of anymore
BY CRAIG D. LINDSEY
AFTER VIEWING MIROIRS NO. 3, I get the feeling Christian Petzold is ready to go Hollywood and make some oldschool melodramas.
















Predominantly set in the German countryside, Miroirs sees writer-director Petzold once again teaming up with actress Paula Beer, making this the pair’s fourth collaboration. This time around, Beer plays Laura, a young woman who’s in a car accident that kills her boyfriend (Philip Froissant), who was driving. Bruised but not broken, she rests and recuperates at the nearby home of Betty (Barbara Auer), a kindhearted middle-aged lady who nurses her back to health.
Laura begins to make herself at home, helping her host by cooking, cleaning and even painting Betty’s picket fence with her. But when Laura meets Betty’s estranged husband (Matthias Brandt, giving Chris Cooper energy) and son (Enno Trebs) — both mechanics who seem concerned about Betty’s well-being — Laura starts to sense Betty might have some traumatic issues of her own.
Although it’s named after the third movement in Maurice Ravel’s Miroirs suite, this is also the final installment in an elemental trilogy that Petzold began with the water-heavy Undine in 2021 and the blazing Afire in 2023. For Miroirs, it’s all about the wind — and although we get shots of curtains delicately swaying in the breeze, the characters still have a hard time clearing the air.
Apart from the opening minutes before the crash — when we see a despondent Laura ruining a getaway she and her boyfriend were having with friends — not much is divulged about Beer’s character, though we slowly learn that Laura is studying piano. Although her character is written as an emotionally ambiguous blank slate, Beer maintains a sympathetic presence, even when she admits she’s not exactly mourning the loss of her significant other. (Considering the movie’s 86-minute run time, I’m gonna assume Petzold cut out a lot of Laura’s backstory.)
Betty and her brood also silently deal with grief. Auer, Brandt and Trebs do quietly devastating work as ordinary people attempting to become a loving family unit again, even when they know welcoming this new gal into the fold won’t bring things back to normal. By having the menfolk repair items in Betty’s house that have been on the fritz, Petzold really lays on the metaphorical emphasis — this clan needs to come together and fix their broken relationship.
Petzold has said in interviews that Alice in Wonderland was an influence on Miroirs, with Beer’s protagonist passing through the looking glass (a fancy term for mirror, naturally) and tak-
ing a spirited journey that could be cut short by that bucket of cold water known as reality. I’ve already seen a critic or two compare Miroirs to Cinderella, another fairy tale about a gal who escapes her miserable existence to briefly become the belle of the ball. (And it’s true that Laura is found missing one shoe after the car wreck.)
But I feel Petzold is also giving a shoutout to David Lynch’s Mulholland Drive — another film about a woman named Betty (Naomi Watts) looking after a brunette (played by Laura Harring) who was in a bad auto accident. And of course, since Lynch’s fascination with The Wizard of Oz is well-documented (perhaps you’ve seen the documentary Lynch/Oz, which played at the Belcourt last year), let’s throw L. Frank Baum’s iconic fantasia into the influence stew. After all, isn’t this family just a trio of lost souls hanging onto a girl who’ll hopefully help them find some heart, brains and courage?
Despite its persistence in keeping things unspoken right down to its final minutes, Miroirs No. 3 is still the most accessible film out of Petzoid’s triumvirate. I can see this film being a favorite for both cineastes and moviegoers looking for a good cry. It reminds me of those tearjerking, family-drama features Hollywood used to make before clogging multiplexes with the latest hot IP. I could imagine this movie getting remade for American audiences, with an A-list cast and a lot more weepy moments. (Petzold, being the subdued German he is, keeps the waterworks to a minimum.)
Unfortunately, these days those types of stories are usually stretched out into eight-part prestige series on streaming platforms. But if studios ever come around to making those films again, I’m pretty sure Petzold wouldn’t mind coming to America and taking a crack at it. ▼

46 ___ Romanoff a.k.a. Black Widow
1 8’ 4” 8 250,000 sheets
14 Short piece of classical music 15 Accessory for SpongeBob SquarePants 16 Long-tongued animal 17 Laudanum, e.g.
18 Calif. M.L.B. team, on scoreboards 19 Happening
21 Collectively, the reigns of all English monarchs named George
26 Grill, informally
29 Bit of mining equipment
30 It’s not pretty
32 Walt Disney’s middle name
34 Like a plane, informally
35 System in which XL is smaller than L … or a hint to interpreting the answers to the italicized clues
40 Malarkey
41 “Stompin’ at the ___” (Benny Goodman standard)
42 “Based on my research …”
50 Vibe (with)
51 Superhuman strength, mindreading, invisibility and four dozen other powers
53 Vexing
54 Title for a certain union member?
55 Like cats and dogs
58 Stall, e.g.
63 Charge, in a way 64 Loose, as floorboards
⎕⎕⎕⎕⎕
66 Total on a chiliagon DOWN
1 Nicolas Cage film set on a plane
2 Amount measured in calories
3 Highland refusal
4 Org. that runs the “L”
5 Alternative to a walk
6 67.5 deg. on a compass
7 ___ Connor, the Terminator’s target in “The Terminator”
ANSWER TO PREVIOUS PUZZLE
8 Wilted
9 Peaceful state 10 Make some alterations
___ minimum 12 Cambridge sch. 13 Get 14 Sudden attack 20 “Bah!”
22 Workers who sing the opening number in “Frozen”
23 Queen of the Pride Lands
24 Friendly look
25 Ending of seven country names
26 Poke ___ 27 Dudes
28 End of a proof
31 Patronize, as an Airbnb
33 Questionable, in slang
35 Side dish eaten with curry
36 Roundish, say
37 Salon job, informally
38 Assessment, informally
39 Side dish eaten with curry
40 Some fancy footwork 43 Dirtbag 44 Parts of naves 45 Animal in some traditional Tibetan races
47 Like a fish out of water, e.g. 48 Mercury’s mythological counterpart
49 Half-___ (subpar, in slang)
52 “Dagnabbit!” 53 Grand ___ 55 Shots, informally 56 Toss up?
57 One, south of the border
59 “Ballerina” star ___ de Armas
You can stop right there!
Remind too often
Up to




FORECLOSURE SALE NOTICE
WHEREAS Dowling Capital Investments LLC, a Tennessee limited liability company, executed a Deed of Trust dated May 1, 2024, of record at Instrument No. 202405030032429, Register’s Office for Davidson County, Tennessee (the Deed of Trust”) and conveyed to “ Smith.Sholar.Milliken.PLLC, as Trustee, the hereinafter described real property to secure the payment of certain indebtedness (“Indebtedness”) owed to Timothy W. Burrow (referred to as “Lender”); and WHEREAS default in payment of the Indebtedness secured by the Deed of Trust has occurred; and WHEREAS David M. Anthony (“Trustee”) has been appointed Substitute Trustee by Lender by that Appointment of Substitute Trustee of record at Instrument 20260325-0023722, Register’s Office for Davidson County, Tennessee, with authority to act alone or by a designated agent with the powers given the Trustee in the Deed of Trust and by applicable law; and WHEREAS Lender, the owner and holder of said Indebtedness, has demanded that the real property be advertised and sold in satisfaction of said Indebtedness and the costs of the foreclosure, in accordance with the terms and provisions of the loan documents and Deed of Trust. NOW, THEREFORE, notice is hereby given that the Trustee, pursuant to the power, duty and authority vested in and imposed upon the Trustee under the Deed of Trust and applicable law, will on Friday, April 24, 2026, at 11:00 o’clock a.m., prevailing Nashville time, on the steps of the historic Davidson County Square, Courthouse, Nashville, 1 Public Tennessee 37201, offer for sale to the highest and best bidder for cash and free from all rights and equity of redemption, statutory right of redemption or otherwise, homestead, dower, elective share and all other rights and exemptions of every kind as waived in said Deed of Trust, certain real property situated in Davidson County, Tennessee, described as follows: Legal Description: The real property is described in the Deed of Trust at Instrument 202405030032429, Register’s Office for Davidson County, Tennessee.
Being
in said Deed of Trust, certain real property situated in Davidson County, Tennessee, described as follows: Legal Description: The real property is described in the Deed of Trust at Instrument 202405030032429, Register’s Office for Davidson County, Tennessee.
Being Lot No. 11 of Black A, on the map of Crolywood Subdivision, Section I, as of record in Book 1130, page 65, Register's Office for said County, Beginning at a point in the Southerly margin of West Bend Road, the common comer of Lots Nos. 11 and 12; thence with the line between said lots, Southerly 153.5 feet to a point, the common corner of said lots and of lots Nos 3 and 4; thence with the line between Lots Nos, 11 and 4, Easterly 70 feet to a point, the common corner of Lots Nos. 4 and 5; thence with the line between Lots Nos. 11 and 5 and 6, Northeasterly 77 feet to the corner of Lot No. 10; thence with the line between Lots Nos. 10 and 11, Northwesterly 160.1 feet to the Southerly margin of West Bend Road; thence with the margin of said road, Southerly 30 feet to a point, and continuing with the same, Southwesterly around a slight curve, 30.24 feet to the point of beginning.
Being the same property conveyed to Dowling Capital Investments, LLC, from William M. Bentley and Ruby J. Bentley, by Warranty Deed filed of record on May 1, 2024, in Instrument No. 20240501-0031653, Registers Office for Davidson County, Tennessee.
Map/Parcel No: 091-13-0-197.00
Street Address: The street address of the property is believed to be 407 West Bend Drive, Nashville, Tennessee 37209, but such address is not part of the legal description of the property. In the event of any discrepancy, the legal description herein shall control. Other interested parties: Metropolitan Government of Nashville & Davidson County – 413; BFS Group, LLC (20250714-0055233); Claudia P. Hile (20250904-0070573); Douglas Coomer; Hailee Long Coomer;
0
Maria Leon; Brigette Diaz; Francisco Diaz Ortegel; Daniel Ramirez Pina; Experienced Construction, LLC (20250909071956); Maximillian Potter Dowling.
THIS PROPERTY IS SOLD AS IS, WHERE IS AND WITH ALL FAULTS AND WITHOUT ANY REPRESENTATIONS OR WARRANTIES OF ANY KIND WHATSOEVER, WHETHER EXPRESSED OR IMPLIED, AND SUBJECT TO ANY PRIOR LIENS OR ENCUMBRANCES, IF ANY. WITHOUT LIMITING THE GENERALITY OF THE FOREGOING, THE PROPERTY IS SOLD WITHOUT ANY REPRESENTATIONS OR WARRANTIES, EXPRESSED OR IMPLIED, RELATING TO TITLE, MARKETABILITY OF TITLE, POSSESSION, QUIET ENJOINMENT OR THE LIKE AND WITHOUT ANY EXPRESSED OR IMPLIED WARRANTIES OF MERCHANTABILITY, CONDITION, QUALITY OR FITNESS FOR A GENERAL OR PARTICULAR USE OR PURPOSE. As to all or any part of the Property, the right is reserved to (i) delay, continue or adjourn the
Maria Leon; Brigette Diaz; Fran-
cisco Diaz Ortegel; Daniel Ramirez Pina; Experienced Construction, LLC (20250909071956); Maximillian Potter Dowling. J 0
THIS PROPERTY IS SOLD AS IS, WHERE IS AND WITH ALL FAULTS AND WITHOUT ANY REPRESENTATIONS OR WARRANTIES OF ANY KIND WHATSOEVER, WHETHER EXPRESSED OR IMPLIED, AND SUBJECT TO ANY PRIOR LIENS OR ENCUMBRANCES, IF ANY. WITHOUT LIMITING THE GENERALITY OF THE FOREGOING, THE PROPERTY IS SOLD WITHOUT ANY REPRESENTATIONS OR WARRANTIES, EXPRESSED OR IMPLIED, RELATING TO TITLE, MARKETABILITY OF TITLE, POSSESSION, QUIET ENJOINMENT OR THE LIKE AND WITHOUT ANY EXPRESSED OR IMPLIED WARRANTIES OF MERCHANTABILITY, CONDITION, QUALITY OR FITNESS FOR A GENERAL OR PARTICULAR USE OR PURPOSE.



any discrepancy, the legal description herein shall control. Other interested parties: Metropolitan Government of Nashville & Davidson County – 413; BFS Group, LLC (20250714-0055233); Claudia P. Hile (20250904-0070573); Douglas Coomer; Hailee Long Coomer;
against said property; any restrictive covenants, easements or setback lines that may be applicable;
As to all or any part of the Property, the right is reserved to (i) delay, continue or adjourn the sale to another time certain or to another day and time certain, without further publication and in accordance with law, upon announcement of said delay, continuance or adjournment on the day and time and place of sale set forth above or any subsequent delayed, continued or adjourned day and time and place of sale; (ii) sell at the time fixed by this Notice or the date and time of the last delay, continuance or adjournment or to give new notice of sale; (iii) sell in such lots, parcels, segments, or separate estates as Trustee may choose; (iv) sell any part and delay, continue, adjourn, cancel, or postpone the sale of any part of the Property; (v) sell in whole and then sell in parts and consummate the sale in whichever manner produces the highest sale price; (vi) and/or to sell to the next highest bidder in the event any high bidder does not comply with the terms of the sale. Substitute Trustee will make no covenant of seisin, marketability of title or warranty of title, express or implied, and will sell and convey the subject real property by Trustee’s Quitclaim Deed as Substitute Trustee only. This sale is subject to all matters shown on any applicable recorded Plat or Plan; any unpaid taxes and assessments (plus penalties, interest, and costs) which exist as a lien against said property; any restrictive covenants, easements or setback lines that may be applicable; any rights of redemption, equity, statutory or otherwise, not otherwise waived in the Deed of Trust, including rights of redemption of any governmental agency, state or federal; and any and all prior deeds of trust, liens, dues, assessments, encumbrances, defects, adverse claims and other matters that may take priority over the Deed of Trust upon which this foreclosure sale is conducted or are not extinguished by this Foreclosure Sale. This sale is also subject to any matter that an inspection and accurate survey of the property might disclose. As of July 1, 2025, notices pursuant to Tennessee Code Annotated § 3 at 5-5-101 et seq. are posted online https://foreclosuretennesa third-party internet see.com by posting company. THIS 2nd day of April, 2026. David M. Anthony, Substitute Trustee EXO LEGAL PLLC P.O. Box 121616 Nashville, TN 37212 david@exolegal.com 615-869-0634
NSC 4/2, 4/9, 4/16/26
title or warranty of title, express or implied, and will sell and convey the subject real property by Trustee’s Quitclaim Deed as Substitute Trustee only. This sale is subject to all matters shown on any applicable recorded Plat or Plan; any unpaid taxes and assessments (plus penalties, interest, and costs) which exist as a lien against said property; any restrictive covenants, easements or setback lines that may be applicable; any rights of redemption, equity, statutory or otherwise, not otherwise waived in the Deed of Trust, including rights of redemption of any governmental agency, state or federal; and any and all prior deeds of trust, liens, dues, assessments, encumbrances, defects, adverse claims and other matters that may take priority over the Deed of Trust upon which this foreclosure sale is conducted or are not extinguished by this Foreclosure Sale. This sale is also subject to any matter that an inspection and accurate survey of the property might disclose.
implied, and will sell and convey the subject real property by Trustee’s Quitclaim Deed as Substitute Trustee only. This sale is subject to all matters shown on any applicable recorded Plat or Plan; any unpaid taxes and assessments (plus penalties, interest, and costs) which exist as a lien against said property; any restrictive covenants, easements or setback lines that may be applicable; any rights of redemption, equity, statutory or otherwise, not otherwise waived in the Deed of Trust, including rights of redemption of any governmental agency, state or federal; and any and all prior deeds of trust, liens, dues, assessments, encumbrances, defects, adverse claims and other matters that may take priority over the Deed of Trust upon which this foreclosure sale is conducted or are not extinguished by this Foreclosure Sale. This sale is also subject to any matter that an inspection and accurate survey of the property might disclose.
As of July 1, 2025, notices pursuant to Tennessee Code Annotated § 3 at 5-5-101 et seq. are posted online https://foreclosuretennesa third-party internet see.com by posting company. THIS 2nd day of April, 2026.
As of July 1, 2025, notices pursuant to Tennessee Code Annotated § 3 at 5-5-101 et seq. are posted online https://foreclosuretennesa third-party internet see.com by posting company. THIS 2nd day of April, 2026.
David M. Anthony, Substitute Trustee EXO LEGAL PLLC P.O. Box 121616 Nashville, TN 37212 david@exolegal.com 615-869-0634
David M. Anthony, Substitute Trustee EXO LEGAL PLLC P.O. Box 121616 Nashville, TN 37212 david@exolegal.com 615-869-0634
NSC 4/2, 4/9, 4/16/26
NSC 4/2, 4/9, 4/16/26
Please be advised that production on “9- 1-1: Nashville” Season 1 wrapped on 02/04/26. Any creditor claims must be made by 04/30/26 to the following: Chris Chan 500 S. Buena Vista St., MC 4242 Burbank, CA 91521
NSC 4/2, 4/9, 4/16/26
Director of Religious Activities/Education. Provide spiritual direction, develop and implement initiatives, and organize and lead regular worship services. Employer: The American Baptist Theological Seminary. Location: Nashville, TN. This position may telecommute periodically from a location within normal commuting distance of Nashville, TN, and intermittent domestic travel is required. To apply, please mail a resume to Dr. W. Green, 1800 Baptist World Center Dr. Nashville, TN 37207.
GOT AN UNWANTED CAR??? DONATE IT TO PATRIOTIC HEARTS. Fast free pick up. Patriotic Hearts’ programs help veterans nd work or start their own business. Call 24/7: 1-833-426-0086 (CAN AAN)
MOBILEHELP, AMERICA’S PREMIER MOBILE MEDICAL ALERT SYSTEM. Whether You’re Home or Away. For Safety and Peace of Mind. No Long Term Contracts! Free Brochure! Call Today! 1-877-667-4685 (CAN AAN)
Over 50 guided tours available. Affordable, social and stress-free travel designed for mature travelers. Our tours include accommodations, transportation, baggage handling, sightseeing, entrance fees, a professional Tour Director and select meals. For a limited time SAVE $250 on all tours. Call YMT today 1-866-314-6821 (CAN AAN)
WE BUY VINTAGE GUITARS!
Looking for 1920-1980 Gibson, Martin, Fender, Gretsch, Epiphone, Guild, Mosrite, Rickenbacker, Prairie State, D’Angelico, Stromberg. And Gibson Mandolins / Banjos. These brands only! Call for a quote: 1-833-641-6624 (CAN AAN)
HOME BREAK-INS TAKE LESS THAN 60 SECONDS. Don’t wait! Protect your family, your home, your assets NOW for as little as 70¢ a day! Call 1-833-881-2713 (CAN AAN)

































































































































































































